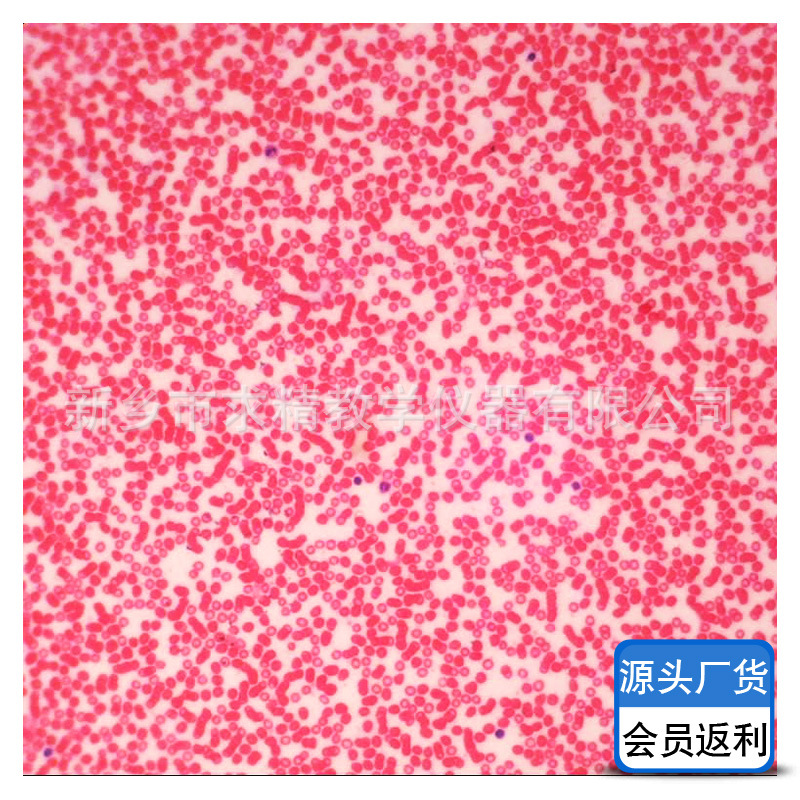

- Categoriya Домашняя страница
- Товары для офиса, школы и проведения мероприятий
- Учебные пособия, муляжи и оборудование
- Биологическое учебное оборудование
Каталог
-
Одежда
- Женская одежда
- Платья
- Пиджаки
- Тренчи и плащи
- Комплекты, распродажа
- Куртка, плащ
- Рабочая/рабочая одежда и униформа
- Женские профессиональные костюмы
- Женские шорты
- Японский стиль для студенов
- Одежда для сцены, танцев
- Одежда для среднего возраста
- Футболка polo
- Спортивные костюмы, легкая одежда
- Джинсы
- Футболки, блузки
- Блузки
- Другая верхняя одежда
- Стиль Лолита
- Свитера
- Пальто
- Кожаная одежда
- Юбки
- Кружевные блузки, шифоновые рубашки
- Майки и топы
- Женский Комбинезон/одежда
- Шубы
- Куртки
- Для влюбленной пары одежда
- Жилеты
- Одежда в обтяжку
- Женские свитера
- Женские брюки, штаны
- Куртки, Пуховики, Жилетки
- Леггинсы, бриджи и лосины
- Женская одежда большого размера
- Плед с рукавами и капюшоном
- кардиган
- Одежда для защиты от солнца
- Одежда для беременных
- Джинсовая куртка
- Ватники и парки
- Азиатский стиль Танга
- Распродажи, комплекты
- Разные платья
- Международная одежда
- Мужская одежда
- Мужские футболки
- Свитера Толстовки Худи
- Мужские повседневные брюки, штаны
- Мужские джинсы
- Мужские куртки
- Спортивная одежда и костюмы
- Мужские рубашки
- Мужские футболки-поло
- Мужские ватники и парки пуховики
- Мужские пуховики
- Мужские пальто
- Мужские ветровки, куртки и парки
- Мужские майки безрукавки
- Мужские бейсбольные куртки
- Мужские свитера и кофты
- Мужская спецодежда и униформа
- Мужские утепленные штаны и брюки
- промо-печать и реклама
- Мужская одежда на заказ
- Мужские товары разные
- Мужские жилеты
- Мужские деловые костюмы
- Мужские шорты
- Повседневная одежда для пар и семьи
- Этническая национальная одежда
- Мужская одежда из кожи и меха
- Одежда больших размеров
- Теплые штаны
- Аниме Косплей Костюмы для семьи
- Разная одежда
- Штаны
- Мужские кожаные брюки и шорты
- ТОЛСТОВКА С КАПЮШОНОМ С МОЛНИЕЙ
- Нижнее белье
- Бельевые аксессуары и наклейки на грудь
- Нижнее белье, сделанное на заказ
- Повседневное белье мужское
- Колготки
- Трусы женские
- Эротическое белье
- Майки, топы, спортивные бюстгальтеры
- Другое нижнее белье
- Носки, чулки, колготки
- Домашняя одежда
- Бюстгальтеры
- Одноразовое белье
- Корректирующее белье
- Термобелье и одежда
- Одежда для спорта и отдыха
- Спортивные утепленные куртки
- Спортивные юбки
- Ветровки для фитнеса
- Штаны для фитнеса
- Спортивные костюмы
- Спортивные футболки и футболки-поло
- Спортивные кофты и толстовки
- Спортивные кофты и ветровки
- Спортивные пуховики
- Спортивные жилетки
- Быстросохнущие майки
- Другая одежда для спорта
- термобелье
- Детская одежда
- Детские шапки
- Джинсовая Одежда
- Детское нижнее белье
- Товары для младенцев
- Защитные перчатки
- Ребенок куртка / жакет / пальто
- Футболка polo
- Одежда на открытом воздухе
- Детские шапки / шарфы / перчатки /Аксессуары
- Пуховики, теплая детская одежда
- Детские юбки, платья
- Пижама
- Детские куртки, пальто и дубленки
- Детские юбки и платья с пышными формами
- Домашняя детская одежда
- КАМПУССКАЯ Одежда
- Детские пуховики и утепленная одежда
- Восточный стиль
- Детская одежда из кожи и кожзама
- Детская традиционная китайская одежда
- Детские футболки
- Детские брюки и штаны
- Детские костюмы: спортивные, праздничные, школьные, домашние и другие
- Детские худи, толстовки и свитера их хлопка
- Комбинезоны, утепленные ползунки и боди
- Детские носки и гольфы
- Детские куртки с хлопковым наполнителем
- Детские рубашки
- Детские свитера
- Детские жилеты
- Тонкие кофты и водолазки
- Детские леггинсы
- Детские комплекты одежды
- Одежда для родителей и ребенка
- Подарочные комплекты одежды для малышей
- Детские трикотажные свитера
- Детские майки
- Детская одежда, сделанная на заказ
-
Обувь
- Женская обувь
- Кросовки кеды
- Шлепки, сланцы, сабо, мюли
- Босоножки, сандалии, летняя обувь
- Босоножки, туфли
- Тапочки, сланцы
- Сандали, и другое
- Босоножки на каблуке
- Женская обувь на платформе
- Сандали, туфли
- Обувь разная
- Полуботинки, сапоги
- Повседневная обувь
- Спортивная обувь
- Ботинки
- Кроссовки, кеды, тенниски
- Туфли
- Кеды
- Зимняя обувь
- Сандали по типу Crocs
- Комфортная обувь
- Обувь для отдыха
- Лоферы
- Утепленная обувь
- Резиновые сапоги
- Классический стиль
- Мужская обувь
- Кросовки
- Спортивная обувь
- Повседневная обувь
- Мужской Стиль пляжные туфли/дырочные туфли
- Кроссовки, кеды, тенниски
- Классические ботинки
- Кеды, мокасины
- Кожаные ботинки и сапоги
- Утепленная обувь
- Шлепки, сланцы, гэта
- Лоферы, мокасины, слипоны, текстильная обувь
- Сланцы
- Летняя обувь
- Зимняя обувь
- Без пятки
- Кожаная обувь
- Мужской Стиль ботинок
- Английский стиль сапоги
- Берцы
- Уличная обувь
- Мокасины
- Резиновые сапоги
- Спортивная обувь
- Бейсбольная обувь
- Милитари обувь
- Теннисные кеды
- Футбольные бутсы
- Обувь для бадминтона
- Обувь для игры в настольный теннис
- Обувь для детей и подростков
- Обувь для бега
- Обувь для йоги и танцев
- Другая спортивная обувь
- Обувь для единоборств
- Баскетбольная обувь
- Детская обувь
- Лоферы, мокасины, слипоны, текстильная обувь
- Ребенок танцевальная обувь
- Родители рекомендуют
- Детская обувь из кожи и кожзама
- Босоножки, сандалии, летняя обувь
- Спортивная обувь
- Тапочки, сланцы
- Ботинки и сапоги
- Кеды
- Обувь для младенцев
- Кроссовки, кеды, тенниски
- Утепленная обувь
- Ребенок угги
- Сапоги, дождевые ботинки
- На младенца туфли
- Обувь со стразами
- по типу Crocks
- Восточный стиль Ханьфу, обувь
- Измеритель обуви
- Обувь, для школьников
- Обувь для туризма и спорта на открытом воздухе
- Кроссовки
- Обувь для скалолазания
- Обувь для горной местности
- Обувь для отдыха
- Походная обувь
- Стельки для спортивной и туристической обуви
- Другая спортивная и туристическая обувь
- Берцы и милитари обувь
- Походная обувь
- Обувь для пляжей и перехода рек
- Домашняя обувь
- Евангелион, тапочки
- Тряпичная обувь
- Пластиковые шлепанцы
- Тканевые шлепанцы и тапки
- Утепленные тапочки
- Стильная обувь
- Обувь для путешествий
- Кожаные и меховые тапочки
- Разная обувь
- Красные тапочки,сандали, сланцы
- Облегчённые, воздушные тапочки
- Обувь Heelys
- Аксессуары для обуви
- Дождевая обувная крышка
- Прибор
- Сплиттер
- Нескользящие палка
- Снег
- Ноги
- Стельки
- Ортопедические стельки и подкладки под пятки
- Обувные пряжки
- Шнурки
- Наклейки на пятки
- Обувная чехла
- Рожок для обуви
- Высокая температура стелька
- Обувь
- Обувь
- Силиконовые подкладки в обувь
- Колодки для обуви
- Комплектующие для обуви
- Комплекты из 2-х предметов
- Разные комплекты
- Обувь, сделанная на заказ
- Наклейки в туфли против скольжения ноги
- Стельки
-
Сумки, рюкзаки, чехлы и чемоданы
- Женские сумки и рюкзаки
- Прозрачные сумки и другие
- Сумки из кожзама
- Другие сумки
- Сумка на плечо
- По магазинам
- Текстильные сумки и рюкзаки
- Маленькая сумка клатч
- Сумки из натуральной кожи
- Небольшая Сумка
- Средняя Сумка
- Большая Сумка
- Сумки и рюкзаки из водонепроницаемой ткани
- Клатчи к вечерним платьям
- Сумки из соломы
- Сумка подмышку
- Сумка на грудь, пояс
- Нательная сумка
- Военные сумки и чехлы
- Поясные сумки, сумки на руку
- Военные рюкзаки
- Другие военные сумки
- На ногу сумки
- Сумки через плечо
- Женские функциональные сумки и косметички
- Другие функциональные сумки
- Косметички
- Бьюти кейсы
- Детские сумки, чемоданы, рюкзаки
- Детские чемоданы для путешествий
- Детские сумки на грудь и пояс
- Сумки через плечо
- Детские модные рюкзаки
- Рюкзаки с держателями для родителей
- Детские кошельки, клатчи и маленькие сумочки
- Сумки и чехлы для цифровой техники
- Влагостойкие сумки и чехлы для фотоаппаратов
- Крепкие кейсы
- Сумки и рюкзаки для фототехники
- Сумки и рюкзаки для фототехники
- Мини сумки
- Детские, подростковые рюкзаки
- Мультяшные рюкзаки
- Детские рюкзаки
- Школьный рюкзак для подростка, подходит для студента
- Рюкзаки для начальной школы
- Школьные портфели
- Школьные рюкзаки на колесиках
- Инерционные сумки
- Сумки и чехлы для ноутбуков и планшетов
- Сумки для ноутбуков и планшетов
- Для Ноутбуков
- Сумки и рюкзаки для ноутбуков
- Спортивные сумки
- Туристические сумки и рюкзаки
- Спортивные рюкзаки
- Спортивные поясные сумки
- Сумки в стиле милитари
- Нашивки на сумки и рюкзаки, аксессуары
- Сумки через плечо
- Сумки на руку для бега
- Водонепроницаемые сумки
- чехлы для музыкальных инструментов
- складной стол сумка
- Чехлы для музыкальных инструментов
- Чехлы, кардхолдеры
- Картхолдеры
- Ключницы, чехлы на ключи
- Другие функциональные чехлы
- Сумки для путешествий
- сумки для телефонов
- Маленькие чемоданы
- Другие сумки
- Кошельки и портмоне
- Женские кошельки
- детские кошельки
- Мужские кошельки
- рюкзаки
- Женский рюкзак
- Рюкзаки и сумки для новорожденных детей
- Рюкзаки
- Рюкзак, для путешествий
- Мужские рюкзаки
- Мужские сумки
- Мужские сумки на грудь
- Мужские сумки на одно плечо
- Мужские разные сумки
- Мужские поясные сумки
- Мужские деловые сумки и портфели
- Мужские портмоне
- Мужские повседневные сумки
- Разные сумки
- Тележка
- Аксессуары, запчасти для сумок и багажа
- Багажная бирка
- Коробка пакет замок
- С застежкой Замок
- Руль
- Универсальное колесо
- Таможенная блокировка
- Другие аксессуары для сумок и багажа
- Кольцо
- Вставлять с застежкой
- Брелоки
- Ремешки для сумок
- Фиксированный блокировка
- Галстук
- Базовый аксессуар
- Багаж
- Аксессуары для багажа
- Сумки на заказ
- Разное, Аксессуары для чемоданов
-
Товары для дома
- Хранение на кухне
- Полки для микроволновой печи
- Контейнеры для хранения еды
- Баночки и бутылочки для специй
- Предметы для кухни
- Контейнеры в холодильник
- Масленки
- Прищепки и зажимы для пакетов
- Другие аксессуары
- Кухонные держатели и полочкиф
- Емкости для хранения столовых приборов
- Сушилки для посуды
- Сито, друшлак
- Держатели для крышек
- Коробочки и банки для круп
- Стойка для кастрюль
- Хранение яиц
- Сушилки и корзины для чистой посуды
- Упаковки для хранения сухого молока
- Полочки для специй
- Все для ванной комнаты
- Полотенцедержатели
- Крючки для ванной и кухни
- Табурет для ванной комнаты
- Ковшик для мытья головы
- Держатели для швабр
- Туалетные ершики и держатели для них
- Мочалки, губки и щетки для тела
- Настольные зеркала, маленькие зеркала
- Детский туалет
- Мыльницы
- Палочки для чистки ушей
- Сидения для унитазов
- Держатели для зубных щеток и паст
- Ванны для тела и ванночки для ног
- Сидения для ванны и ванночки
- Шапочки для защиты глаз от шампуня
- Полки и стойки для ванной
- Шапочки для душа
- Другие принадлежности для ванной комнаты
- Занавески для душа
- Диспенсеры для зубных паст
- Держатели зубных щеток на присосках
- Одноразовые сидения для унитазов
- Ванночки и массажеры для ног
- Комплекты для ванной комнаты
- Ванночки для купания
- Детские лестница для туалета
- Бритвы и инструменты для удаления волос
- Мыльницы на присосках
- Косметички
- Держатели фенов для волос
- Держатели стаканчиков и кружек
- Зонты, защита от дождя, ветра и солнца
- Рыболовные зонтики
- Зонтики ручной работы и основы под роспись
- Декоративные зонтики
- Пляжные зонтики
- Зонтики для гольфа
- Чехол для скутера
- Водонепроницаемая ткань
- Карманные зонты
- Плащи дождевики
- Универсальные зонтики
- Детские Зонтики
- Водонепроницаемые комплекты одежды
- Солнцезащитные зонтики
- Другие плащи и дождевики
- Шляпа-зонтик
- Другая защита от ветра и дождя
- Защита от ветра для мопедов и мотоциклов
- Зонтики для рекламы и промо
- Другие зонтики
- Зонтичная рама/зонтичные аксессуары
- Уборочное оборудование для дома
- Щетки для мелкого мусора
- Щетка для бутылочек
- Тапочки для уборки пола
- Держатели для мусорных пакетов
- Туалет, утка
- Кухонные тряпки
- Швабры
- Металлические мочалки
- Другие инструменты для уборки дома
- Мусорки и емкости под мусор
- Мешки для мусора
- Скребки для стекол
- Фартуки и манжеты
- Губки для мытья посуды
- Тазики
- Резиновые перчатки
- Плоская швабра
- Щетка для унитаза
- Вантузы, чистка раковины
- Мусорки
- Современные швабры
- Собиратель мусора
- Одноразовые рукава и халаты
- Щетка для окон
- Скребок
- Швабра для удаления статической пыли
- Туалетная кисть-ершик
- Чайное ведро, мусорное ведро с отсеками
- Предметы для раковины
- Веники и совки
- Ведра
- Щетки для пыли
- Аксессуары для швабры
- Ленивая тряпка
- разное
- Ящики и коробки для хранения
- Чехлы для костюмов и пальто
- Полка хранения обуви
- Водонепроницаемые чехлы, сумки
- Наборы дорожных чехлов и косметичек
- Другие емкости для хранения
- Ящики для хранения
- Корзины для хранения
- Тканевые мешки и сумочки для хранения
- Коробки и ящики для хранения
- Мешочки и коробочки для ювелирных украшений
- Держатели для туалетной бумаги с полочкой для хранения
- Корзины для грязной одежды
- Подвесные органайзеры для хранения мелочей
- Чехлы для одежды
- Ведра для хранения белья и мусора
- Сумки и корзины для покупок
- Аптечки
- Стеллажи и комоды для хранения
- Стеклянные банки для хранения
- Полки и стеллажи для хранения
- Вакуумные мешки
- Пуфики с отделением для хранения
- Банки и бутылки для хранения
- Стеллаж перфорированный, панель
- Хранение игрушек
- Застежка для одеяла
- Ключница
- Органайзер для капсульного кофе
- Хранение нижнего белья
- Хранение еды
- Хранение косметики
- Хранение помады
- Стойки, коробки и ящички для ювелирных изделий и косметики
- косметички
- Чехлы для зубных щеток
- Гардеробные комнаты
- Органайзер на стену
- Сумки для обедов
- Чехлы для обуви
- Все для стирки, сушки и ухода за одеждой
- Раздвижные палки для снятия одежды
- Стиральные доски
- Плечики и вешалки для брюк
- Ролик для чистки одежды
- Сушилки, плечики, вешалки
- Прищепки
- Мешки для стирки
- Капсулы, шарики для стирки
- Гладильные доски
- Подвесные корзины для сушки
- Вешалки для штанов
- Подъемная сушилка
- Сушилки с множеством креплений
- Вешалки для галстука
- Аксессуары для стирки и сушки вещей
- Товары повседневного спроса
- Товары, удерживающие тепло
- Товары для дома
- USB-устройства для дома
- Товары для отелей
- Весы
- Ящички и разделители для упорядоченного хранения
- Крючки для одежды и полотенец
- Органайзеры и полочки
- Другие приспособления для хранения
- Крючки на бортики, двери и поручни
- Держатели бумажных полотенец и туалетной бумаги
- Стойки и подставки под сфтиральную машинку
- Полочки для ванной комнаты
- Крепления на стену для хранения
- Подставки и держатели для ванной комнаты
- Держатели и наклейки на присосках
- Разделители для ящиков
- Полки и стеллажи для туалетной комнаты
- Приспособление для складывания одежды
- Многоярустные полки, стеллажи
-
Инструмент, Оборудование, Хозтовары
- Нож
- Скаладывающийся нож
- Нож для вырезания
- Складной нож
- С отверстиями нож
- Многофункциональные плоскогубцы
- Лезвие
- Другой нож
- Разные резаки
- Электрические инструменты
- Промышленный пылесос
- Ручная пила, обезьяна
- Диагональная резка
- Электрический фен
- Шуруповерт
- Перфоратор
- Рубанок
- Болгарка
- Головка на дрель
- Шуруповерты
- Ручная дрель
- Промышленный фен
- Электрическое шлифование
- Болгарка
- Электрический молот Перфоратор
- Комплект электрические инструменты
- Шуруповерт
- Резка профиля
- Резка камня
- Электро пила
- Миксер
- Другие электрические инструменты
- Электрический шлифовчик
- Лобзик
- БОШ bosch
- Другие электрические полированные машины
- Дрель перфоратор
- Напильники
- Колесики
- Сельскохозяйственный инструмент
- Вилы
- Лопата
- Снеговая
- Кирка
- Другие сельскохозяйственные инструменты
- Серп
- Мотыга
- Лопатки
- Грабли
- Ящики лестницы
- Стеллажи
- Ящик
- Металлическая сетка
- Лестницы стремянки
- Набор инструментов, комплект
- Набор инструментов, комплект
- Набор инструментов, комплект
- Набор инструментов, комплект
- Комплексный комбинированный инструмент
- Набор инструментов, комплект
- Оборудование для сварки и резки
- Сварочный аппарат
- Сварочный аппарат
- Паяльник
- Садовый инструмент
- Ножницы для изгороди
- Лейка, опрыскиватель
- Цепная пила
- Газонокосилка
- Другие аппаратные инструменты сада
- Секатор
- Бензопила
- Оборудование для подъема и погрузки
- Крючки, петли
- Другое разгружающее оборудование
- Подъемник
- Вышка
- Щипцы
- Пандус Посадочный мост
- Вручную Подъемная платформа автомобиль
- Рука Крэйн
- Домкрат
- Биты, пилки итд
- Бита, головка
- Метчики для резьбы
- Другие расходные материалы для инструментов
- Удлинитель для торцевых гаек
- Резьба комплект
- Пилки
- Сверла
- Резьборез
- Пневматический инструмент
- Пневматическая отвертка
- Пневматическая шлифовальная машина
- Другие пневматические инструменты
- Молоток пневматический
- Пневматические плоскогубцы
- Пневматическая дрель
- Пневматическ пистолет-заклепка
- Пневматический пистолет
- Пневматический насос для масла
- Пневматический распылитель
- Пневматическая лопата
- Пневматический нож
- Пневматическая пила
- Пневматическое перо
- Пневматическая полировка
- Пневматическая болгарка
- Машина пневмо шлифовальная прямая
- Пистолет для герметиков
- Пневматический гаечный ключ
- Миксер пневматический
- Пневматическая пила
- Пневматические ножницы
- Пневматический пистолет для головок
- Пистолет распылитель
- Пневматические аксессуары для инструментов
- Оборудование для СТО
- Другое оборудование для технического обслуживания
- Демонтаж шин
- Камера для покраски
- Подъемники
- Шиномонтаж
- Лампы
- Ремонт шин
- Коррекция робот
- Оборудование для листового металла
- Гаечный ключ
- Труб -гаечный ключ
- Насадка с рукавом
- Другой вручную гаечный ключ
- Внутренний шестигранный гаечный ключ
- Гаечный ключ
- Крючок
- Вручную тянуть перчатки Пакет
- Гаечные ключи
- Гаечный ключ
- Гаечный ключ
- Двойной гаечный ключ
- Колючий ключ
- Живой гаечный ключ
- Степлер
- Инструмент обслуживания
- Коммерческая ткань
- Шприц для масла
- Буксировочный трос
- Лебедка
- Монометр
- Полировка
- Другие инструменты обслуживания
- Набор инструментов
- Катушка для трубок
- Инструмент для мытья автомобиля
- Другие инструменты для мытья машины
- Автомобильная швабра
- Стойка для хранения труб
- Шланг для мытья машины
- Штутцер
- Автомойка
- Пистолет для мойки
- Транспортное оборудование
- Тележка
- Штабелер
- Передвижной стол
- Погрузчик
- Тяговое устройство
- Аксуары для вилочного погрузчика
- Другие инструменты
- Скребок
- Циркуль
- Нож для обрезания трубки
- Пистолет для заклепок
- Другие типы подходящих инструментов
- Щипцы и плоскогубцы
- Плоскогубцы
- Кусачки
- Кусачки
- Многофункциональные плоскогубцы
- Карп Тонг
- Кусачки широкие
- Другие плоскогубцы
- Обжимные щипцы
- Щипцы узкие
- Раздвижные щипцы
- Зачистка кабеля
- Сильные плоскогубцы, с фиксатором
- Диагональные плоскогубцы
- Для стальная проволоки
- Для стопорных колец
- Болторез
- Пила
- Пила по металлу
- Машинная пила
- Пила ручная
- Другая пила
- Ручная пила, деревообработка по дереву
- Шнур, крепеж, стропы
- Цепь
- Крючки, зажимы
- Коуш кольцо
- Соединяющее кольцо
- Вертлюг, Вращение кольцо
- Талереп
- Крюк
- Стропы
- Рукав, стропы
- Стальной трос
- Стяжной ремень
- Рубанок
- Инструмент для стекла и дерева
- Стеклорез
- Шпатель
- Присоски для стекла
- Мастерок
- Рубанок небольшой
- Другие инструменты
- Гидравлический инструмент
- Гидравлический захват
- Гидравлическое давление проволоки плоскогубцы
- Гидравлический гаечный ключ
- Гидравлические ножницы
- Другие гидравлические инструменты
- Гидравлические плоскогубцы
- Измерительные приборы
- Штангель - циркуль
- Измерительный прибор Процент
- Микрометр
- Глубинометр
- Секундомер
- Линейка
- Транспортир
- Цифровой штангельциркуль
- Разные измерительные приборы
- Стандартный штангельциркуль
- Другие инструменты
- Сварка и аксессуары
- Вакуумный паяльник
- Электроды
- Сварочный наконечник
- Сварка олово проволока
- Зажим
- Сварочный порошок
- Флюсовая паста
- Паяльная железная головка, паяль
- Другие сварочные материалы и аксессуары
- Сварочная проволока
- Инструмент для труб
- Ножницы для трубы
- Трубогиб
- Другие инструменты для труб
- Расширитель для труб
- Индоскоп
- Газовый ключ, Трубные гаечные ключи
- Верстак
- Ящик для инструментов
- Отвертка
- Маленькая отвертка
- Минусовая отвертка
- Шестигранник
- Многофункциональная отвертка
- Отвертка с насадками
- Комплект отверток
- Разные отвертки
- Ручная отвертка
- Пинцет
- Кисточка, Щетка
- Распылитель
- Насос
- Долото, стоместка
- Ножницы
- Ножницы
- Ножницы для ткани
- Ножницы по металлу
- Другие ножницы
- Медицинские ножницы
- Клепки застежки
- Клипсодер
- 3д 3D принтер
- Алмазный инструмент
- Абразивные товары
- Абразивный круг
- Металлический круг
- Шлифовальный блок
- Полировочный круг
- Ткань для протирки
- Page Wheel, Page Film
- Наждачка
- Натуральный абразив
- Наждачная бумага
- Абразивная губка
- Шлифовальная паста
- Другой абразив
- Полирующее колесо
- Диски для резки
- Наждачная бумага
- Шлифовальные головки
- Шлифовальная лента
- Шлифовальный круг
- Другое шлифовальное снаряжение
- Полировательный крем
- Молоток
- Топор
- Надежный инструмент
-
Спорт, туризм
- Верхняя одежда для туризма и спорта
- Ветровки
- Одежда для альпинизма
- Одежда для страйкбола, милитари одежда
- Куртки и брюки с ветро и влаго защитой
- Быстросохнущие футболки
- Повседневные штаны
- Кофта
- Быстросохнущие штаны, брюки
- Одежда с флисовой подкладкой
- Термобелье, другая одежда
- Утепленная одежда и ватники
- Мотоциклетная одежда
- Водные виды спорта
- Маски и трубки для плавания
- Байдарки
- Водолазные перчатки
- Водонепроницаемые сумки, чехлы и мешки
- Фонари и освещение для дайвинга
- Ласты
- Одежда для плавания и дайвинга
- Водный мотоцикл
- Весла, плавники
- Надувные матрацы и круги
- SUP Серфинг и виндсерфинг САП САПЫ
- Надувные лодки
- Товары для дайвинга
- Другое оборудование для плавания
- Обувь для плавания
- Аксессуары для прогулочных лодок
- Парусные лодки
- Очки для спорта и туризма
- Пуленепробиваемые очки
- Очки для вождения
- Очки для езды
- Очки для плавания
- Очки для спорта
- Очки для лыж и гор
- Оборудование для фитнеса
- Ростомер
- Тренировка ног
- Круг
- Стэп
- Нагрузочное оборудование
- Эллиптическая машина
- Фитнес скамьи и стулья
- Эспандер, тренировка рук
- Гироскоп
- Растяжки
- Летающая тарелка
- Гиря
- Турник
- Фитнес зеркало
- Танцевальные коврики
- Гребные тренажеры
- Спортивное резиновое покрытие
- Инверсионный стол
- Инвентарь и тренажеры для прыжков
- Другое оборудование для фитнеса
- Тренажеры для пресса
- Фитнес ленты и экспандеры
- Скакалки
- Беговая дорожка
- Тренажеры для бокса
- Турники и уличные тренажеры
- Обручи
- Батут
- Товары для тяжелой атлетики
- Фитнес инвентарь
- Вибромассажеры для похудения
- Степперы
- Велотренажеры
- Гантели
- Коньки, ролики, скейты, самокаты
- Самокаты
- Waveboard, скейтборды
- Роликовые коньки
- Ледовые коньки
- Спортивное защитное снаряжение
- Защита на локти
- Защита на плечи
- Гимнастические коврики и маты
- Шлем, Защита головы
- Наколенники
- Фиксаторы поясницы
- Другое спортивное защитное снаряжение
- Защитные рукавицы и перчатки
- Защита запястий
- Комплекты защиты
- Защита на лодыжки
- Фиксаторы для бедер и ног
- Футбольная продукция
- Футбольные ворота
- Футбольные гетры и носки
- Перчатки для вратаря
- Тренировочная форма, манишки
- Щитки
- Тактические панели
- Сумки для мячей и формы
- Футбольная форма
- Снаряды для тренировок
- Футбольные мячи
- Сувенирная продукция
- Футбольные аксессуары
- Массажное и медицинское оборудование
- Турмалиновый массаж
- Массажные аксессуары и инструменты
- Аксессуары для здоровья
- Устройства для похудения
- Защитное снаряжение и фиксаторы
- Волейбол
- Волейбольные мячи
- Волейбольная обувь
- Волейбольная форма
- Другие аксессуары для игр с мячом
- Теннис и бадминтон
- Теннисные сумки
- Сетка для тенниса
- Амортизаторы ударов
- Другие теннисные аксессуары
- Одежда для большого тенниса
- Одежда для бадминтона
- Сетка для бадминтона
- Теннисный мячик
- Оплетки для рукоятей и аксессуары для ракеток
- Ракетки для бадминтона
- Валанчики
- Леска для ракеток
- Сумки для бадминтона
- Другое оборудование для бадминтона
- Одежда для йоги и фитнеса
- Спортивные термо-кофты и футболки
- Футболка для йоги
- Мини-юбка для йоги
- Комбинезон для йоги
- Одежда для йоги
- Куртка для йоги
- Одежда для йоги
- Штаны для йоги
- Шорты для йоги
- Одежда для гимнастики, черлидинг
- Одежда для йоги
- Спортивные термо-штаны
- Спортивная одежда
- Спортивный топ, бюсткалтер
- Костюмы для фитнеса
- Спортивная форма и одежда для боевых искусств
- Одежда для боевых искусств
- Одежда для тхэквондо и дзюдо
- Спортивная форма
- Другая спортивная форма
- Одежда и аксессуары для конного спорта
- Танцевальные костюмы
- Спортивные аксессуары
- Спортивные браслеты и кольца
- Пульсометры
- Сумки для плавания
- Повязки на голову
- Головные уборы и шарфы
- Рукава
- Чехлы от дождя на сумки, рюкзаки и велосипеды
- Оборудование для проверки здоровья
- Боулинг
- Шары и кегли
- Кегли
- Дорожки для боулинга
- Оборудование для боулинга
- Аксессуары для боулинга
- Баскетбол
- Сувенирная продукция
- Баскетбольная форма
- Сумки для мячей и формы
- Тактические панели
- Баскетбольные мячи
- Баскетбольные корзины и стойки
- Принадлежности и аксессуары
- Запчасти для велосипеда
- Велосипедный звонок
- Велосипедная корзина
- Велотормоза и ручки
- Велосипедные звездочки, шатуны
- Велосипедные колеса
- Велосипедные обода
- Велосипедные спицы
- Велосипедные зеркала
- Велосипедные амортизаторы
- Велосипедные украшения и тюнинг
- Велосипедные инструменты
- Велосипедные фары и фонари
- Другие запчасти для велосипедов
- Велосипедные рамы
- Велосипедные педали
- Велосипедные седла
- Велосипедные колеса и шины
- Велосипедные оси и втулки
- Переключатели скоростей
- Велосипедные цепи
- Велотормоза колодки
- Велопкомпьютеры, трекеры
- Велосипедные звездочки, кассеты
- Велосипедные вилки
- Йога
- Кирпичи для йоги
- Растяжки для йоги
- Пилат
- Пузырьковый вал, валик
- Полотенце для йоги
- Кольцо для йоги/йога
- Другое оборудование для йоги
- Коврики для йоги
- Мячи для йоги
- Гольф
- Клюшки для гольфа
- Мячи для гольфа
- Сумки и чехлы для гольфа
- Наборы для гольфа
- Колышки для мяча
- Гольфкары
- Одежда для гольфа
- Аксессуары и тренажеры для гольфа
- Софтбол, хоккей
- Биты и клюшки
- Мячи и шайбы
- Тренировочные мячи
- Бейсбольные мячи
- Все для настольного тенниса
- Одежда для настольного тенниса
- Покрытие для настольного тениса
- Основа ракеток для настольного тенниса
- Чехлы и сумки для настольного тениса
- Столы для настольного тенниса
- Сетки для настольного тенниса
- Машины для подачи мячей
- Аксессуары настольного тенниса
- Оборудование для уборки
- Ракетки для настольного тенниса
- Другие аксессуары для настольного тенниса
- Мячи для настольного тенниса
- Оснащение игровых площадок и аттракционы
- Оборудование и горки для аквапарков
- Картинг машины
- Карусели
- Качели-балансиры
- Спортивные и канатные городки
- Плавательные бассейны
- Другое игровое оборудование
- Спортивные городки
- Игровые комплексы и батуты
- Качели маятниковые
- Товары для экстремальных видов спорта
- Одежда для парашютного спорта
- Парапланеризм
- Другие товары для экстремальных видов спорта
- Страховочное снаряжение и веревки
- Бильярд
- Бильярдный кий
- Бильярдные столы
- Бильярдные шары
- Бильярдные аксессуары
- Другие спортивные товары
- Спортивная одежда изготовленная на заказ
- Американский футбол, сквош, гандбол
- Мячи для американского футбола
- Регби
- Мячи для сквоша
- Мячи для гандбола
- Оборудование для игры с мячом
- Сетки
- Колонны и стойки
- Ворота
- Другое оборудование для игры с мячом
- Машины для подачи мячей
- Стрельба из лука
- Фехтование, принадлежности для боевых искусств
- Покрытие для спортивных площадок и стадионов
- Искусственная трава
- Судейское оборудование
- Тактические доски, карточки замены
- Другое судейское оборудование
- Шагомеры
- Секундомеры и таймеры
- Свистки
- Настольные спортивные игры
- Шахматы
- Маджонг
- Другие настольные игры
- Настольный футбол и настольный хоккей
- Карты Покер
- Китайские шахматы, го
- Вытяжка Маджьян Машина
- Кости и фишки
- Чемоданчики покерные
- Дартс
- Рыболовные принадлежности
- Освещение для ночной рыбалки
- Костюмы для туризма, рыбалки
- Очки для рыбалки
- Рыболовные зонты
- Рыбацкие лодки
- Другие рыболовные принадлежности
- Удочки
- Подсачеки, садки, багры, куканы
- Рыболовные приманки
- Рыболовные катушки
- Подставки, стойки, род-поды
- Рыболовные крючки
- Рыбацкая одежда
- Рыболовные сумки и чехлы
- Леска
- Поплавки стандартные
- Рыболовные кресла
- Эхолоты
- Комплекты рыболовных принадлежностей
- Обувь для рыбалки
- Грузило
- Рыболовная снасть комплект
- Гнездовая лодка для прикорма
- Проводка натяжитель
- Сачок
- Космические бобы поплавки
- Рыболовный гарпун
- Сетка
- Сумка для пойманной рыбы
- Зажим
- Рыбацкие шапки, кепки, головной убор
- Рыбацкие штаны
- Удленитель Сборщик
- Коробки и ящики
- Альпинизм, скалолазание, ледолазание
- Товары для туризма и кемпинга
- Палатки и аксессуары для палаток
- Складные столы и стулья
- Другие товары для туризма
- Влагостойкие коврики и коврики для пикника
- Светильники, фонари и освещение для кемпинга
- Туристическая посуда
- Надувные матрацы и кровати
- Горелки и таганки
- Налобные фонари
- Гамаки
- Спальные мешки
- Карабины
- Треккинговые палки
- Бинокли
- Палатка
- Раскладушки
- Камуфляжная сетка
- Запчасти для кемпинга
- Приборы ночного видения
- Сигнальный и спасательный свет
- Тележка для кемпинга
- Шатер
- Туристические наручные часы
- Компасы
- Мат, подушка
- Товары для конного спорта
- Лыжи, сани, сноуборд и катание по снегу
- Горнолыжные костюмы
- Ботинки для лыж и сноубордов
- Все для катания со снежных горок
- Другие принадлежности для зимних катаний
- Сноуборд
- Лыжный комбинезон, штаны термобелье
- Горнолыжные штаны
- Лыжная куртка
- Лыжные двойные панель
- Тюбинги Ватрушка
- Горнолыжный шлем
- Крепления для сноуборда
- Горнолыжные перчатки
- Чехол для лыж и ботинок
- Защита таза
- Лыжный набор инструментов
- Лыжная палка
- Лыжный аксессуар
- Сани панель
- Велосипеды, Гироскутеры, Сигвеи
- Горные велосипеды
- Детские велосипеды
- Другие велосипедные принадлежности
- Велосипедные шлемы
- Велосипеды
- Складные велосипеды
- Гироскутеры, Беговел и сегвеи
- Велосипеды для путешествий
- BMX
- Другие велосипеды
- Моноколеса
- Городские велосипеды
- Велосипеды с переменной скоростью
- Тандемы
- Шоссейные велосипеды
- Велосипеды для родителя и ребенка
- Купальники и принадлежности для плавания
- Парео и накидки
- Шапочки для купания
- Мужские купальные трусы и гидромайки
- Другие принадлежности для плавания
- Семейные купальники
- Раздельные купальники
- Слитные купальники
- Надувные круги для плавания
- Детские купальники
- Аксессуары для плавания
- Парео, защита от солнца на пляже
- Плавки для купания
- Купальники с накидками
- Езда на велосипеде
- Маски для защиты лица
- Велосипедные перчатки
- Велосипедные сумки
- Велосипедная обувь
- Велосипедные рюкзаки
- Велосипедная одежда разная
- Одежда для велоспорта
- Товары для гимнастики
- Аксессуары для танцев
- Товары для легкой атлетики
-
Игрушки и развивающие игры
- Игрушки из мультфильмов и игр
- Модели и фигурки
- Копия персонажей
- Модельная игрушка
- Копия меча
- Копия фрукты и овощи/игрушки для еды
- Игрушки динозавров
- Копия еды
- Копия животных
- Модели автомобилей
- Аниме фигурки
- Модели военной техники
- Модели самолетов
- Другие фигурки и модели
- Динозавры, животные, птицы
- Сборные модели роботов и трансформеры
- Модели домов
- Модели кораблей, яхт, лодок
- Ростка
- Электронные и светящиеся игрушки
- Электронные игрушки
- Люминесцентные палочки
- Светящиеся браслеты
- Светящиеся шары, игрушки
- Надувные игрушки и игровые зоны
- Большие надувные фигурки
- Крупные надувные игрушки и игровые батуты
- Другие надувные игрушки и костюмы
- Куклы и аксессуары
- Кукла игрушечные аксессуары
- Кукла
- Кукольная коляска
- Игрушки для кукольного дома
- Кукольная мебель
- Конструкторы игрушки
- Средних размеров
- Снежинки
- Домино
- Электроника
- Большие фигурки
- Детские Музыкальные игрушки
- Детские Электронное пианино
- Шкатулка
- Барабан
- Дудки
- Мелафон
- Приколы и Розыгрыши
- Смешные игрушки
- Шарики с игрушкой
- Игрушки на солнечных батареях
- Резиновые игрушки
- Игрушки на магните
- Магнитные кубики
- Игрушки приколы
- Другие приколы и шутки
- Декомпрессионная игрушка
- Магия и фокусы
- Сюрприз игрушка
- Индукционные игрушки
- Другие творческие игрушки
- Плюшевые игрушки
- Подвеска
- Кукольная подушка
- Кукол плюшевые
- Талисман кукла
- Копия Аутентичный
- Современные куклы
- Мягкие игрушки на диван
- Восточные игрушки
- Коляски, велосипеды
- Машины-каталки
- Детские коляски
- Ходунки
- Беговел
- Поводок для детей
- Коляски
- Детские электромобили
- Детские самокаты
- Рюкзаки-переноски и слинги для детей
- Трехколесные велосипеды
- Детские велосипеды
- Ходунки
- Аксессуары для колясок и сидений
- Другие игрушки
- Колыбели и качалки
- Развивающие игры, головоломки и конструкторы
- Пирамидки
- Разборка/комбинированные игрушки
- Сенсорное обучающее оборудование
- Обучение разума
- Интеллектуальные игрушки
- Домики, машинки
- Когнитивные/спаривающие игрушки
- Игрушки для научного эксперимента
- Игрушка для младенца, для ползания
- Обучающие часы
- Калейдоскопы
- Археологическая роскошная игрушка
- Развивающие карточки
- Магнитная пленка/магнитный шарик/магнитный строительный блок
- Геометрическая форма
- Счеты
- Грибы, бусы
- LEGO и аналоги
- Другие головоломки
- Конструкторы типа лего
- Пазл
- Научные и образовательные игрушки
- Доски для рисования
- Обучающие компьютеры для детей
- Детские музыкальные инструменты
- Глина, песок, пластилин
- Кубики Рубика
- Лабиринты
- Головоломки
- Архитектура DIY CABIN TOY
- Бусины игры и создание украшений
- Еда
- Наборы для раскрашивания
- Полимерная глина
- Настольные игры детские
- Слинки пружинка
- Игрушка для ловли рыбы
- Игровые наборы
- Маленькие домашние игрушки
- Наборы посуды и игрушечные кухни
- Другие наборы для игры
- Наборы для детского макияжа
- Набор врача
- Кукольные домики
- Наборы для создания украшений и бижутерии
- Мебель в кукольные домики
- Детские инструменты
- Игрушки на дистанционным управлением
- Электронные животные
- Танки на пульте управления
- Машинки на пульте управления
- Самолеты, вертолеты, квадракоптеры
- Детское оружие
- Инерционные игрушки
- Другие игрушки
- Автотреки
- Электронные куклы
- Заводные игрушки
- Детские электромобили
- Авиационная игрушка
- Катера на пульте управления
- Игрушки для малышей
- Колыбели и качалки
- Игрушка для ванной комнаты
- Мячик для рук
- Барабаны
- Успокаивающая игрушка
- Мягкие резиновые блоки
- Неваляшка
- Коробочки для хранения молочных зубов
- Манеж, домики
- Игрушки в кроватку
- Другие обучающие игры для малышей
- Игровые манежи и коврики
- Тканевые книжки
- Игрушки в коляску
- Детские ходунки
- Игровые коврики
- Качели домашние
- Игрушка молоток
- Толкайте игрушку
- Игрушка для младенца
- Погремушка
- Игрушка для младенца для фитнеса
- Куклы и мягкие игрушки
- Плюшевые игрушки
- Другие куклы
- Куклы младенцы и малыши
- Куклы
- Аксессуары для кукол
- Цветочная кукла
- Тряпичные куклы
- Аксессуары для украшения торта
- Марионетка
- Игрушки сделанные на заказ
- Игрушки разные
-
Товары для офиса, школы и проведения мероприятий
- Аксессуары для ключей
- Автомобильные брелоки
- Брелок
- Брелок, аксессуар
- Офисные шкафы, стойки и системы хранения
- Газетные стойки
- Архивные папки
- Диспенсеры для стикеров и клейких блоков
- Настольные картотеки
- Папки и системы архивации
- Настольные визитницы
- Канцелярские аксессуары
- Книги для хранения коллекций
- Зажим для бумаг
- Канцелярские зажимы для бумаг
- Фотоальбомы
- Планшетки
- Папки-конверты
- Другие принадлежности для хранения
- Наборы файлов
- Кейсы и чехлы для дисков
- Файловые папки
- Лотки и накопители для бумаг
- Карманные визитницы
- Папки-портфели
- Визитницы настольные
- Свадебные принадлежности
- Красные конверты
- Свадебный Бюст
- Цветок на запястье
- Свадебные постельные принадлежности
- Марля/занавес вуаль
- Наклейки со словом «Счастье»
- Свадебные подарки
- Свадебные букеты, цветы
- Талисман на здоровое потомство
- Украшение свадебного автомобиля
- Галерея дверь /Game Reps
- Арки и украшения
- Подарочные коробки конфет
- Другие свадебные принадлежности
- Рождество и европейский новый год
- Другие рождественские украшения
- Новогодние шары, украшения на елку
- Рождественская юбка для елки, подложка
- Рождественские кольца
- Рождественские колокольчики
- Рождественские украшения
- Новогодние ёлки
- Искусственный снег и снежинки
- Канцтовары для учебы
- Циркули
- Чернила для письма, рисования и принтеров
- Прописи для иероглифов
- Корректирующая жидкость, корректор
- Наклейки
- Пеналы-косметички
- Наборы канцтоваров
- Подставки для ручек настольные
- Пеналы-коробки
- Закладки
- Ластики, стиралки
- Точилки для карандашей
- Держатели для книг настольные
- Корректор лента
- Подставки для книг настольные
- Обложки для книг и тетрадей
- Всё для праздников
- Китайские Фонари
- Офисные подарочные коробки и пакеты
- Украшения на хэллоуин
- Другие праздничные принадлежности
- Китайские плетеные украшения
- Подарочные коробки
- Другие украшения и аксессуары к празднику
- Небесные фонарики
- Фейерверки, салюты
- Офисная бумага
- Бумага для печати
- Кассовая бумага и лента
- Бумага для офисной техники
- Бумага для компьютеризированной техники
- Бумага для струйной цветной печати
- Бумага для факсов
- Бумага для письма и каллиграфии
- Бумага для рисования
- Другая офисная бумага
- Бумага для копирования
- Этикетки
- Фотобумага
- Административные принадлежности
- Сертификаты, дипломы и грамоты
- Медали и награды
- Крепление для бейджиков на рулетке
- Карточки рассадки гостей
- Подарочные конверты
- Гостевые книги
- Кубки и награды
- Медали
- Аниме/кино и телевидение/звезды
- Аниме/Звездный украшение
- Реквизит
- Аниме кулон брелок
- Реквизит, косплей
- Аниме фигурки
- Похоронные принадлежности
- Похороны
- Яблочная коробка/алтарь/банка
- Гроб
- Жертва благовония печи/печи Ding
- Сумка трупа
- Монтер/бумажные деньги
- Бумажная жертва
- Жертва свеча
- Венок
- Lingtang Mayout Supplies
- Надгробия
- Духовная карта
- Влагоотталкивающий
- Shouyi/обувь/шляпа
- Похороны
- Поднимать
- Сбрасывать
- Канцтовары для финансового учета
- Ваучер-отчеты
- Счёты
- Чемоданчики для инкассации и хранения денег
- Муляжи денег
- Копировальная бумага
- Бухгалтерская книга
- Печати
- Другие канцтовары для финансового учета
- Учебные пособия, муляжи и оборудование
- Авто и мото учебное оборудование
- Математическое учебное оборудование
- Глобус
- Мегафоны, орало, громофон
- Учебное оборудование по географии
- Мультимедийное учебное оборудование
- Биологическое учебное оборудование
- Электромеханическое учебное оборудование
- Медицинское учебное оборудование
- Указки
- Идеи для подарка
- Подарок промышленного бренда подарок
- Рекламный фанат
- Тарелка Сувенир
- Поп -рекламная бумага/наклейка с взрывом
- Рекламная палатка
- Карточка участника
- Украшение богатства
- Значок
- Бизнес подарок комплект
- Канцтовары для переплета и скрепления
- Скотчи и клейкие ленты
- Дыроколы
- Скобы для степлеров
- Датеры и нумераторы
- Булавки и гвоздики
- Скрепки и прищепки
- Мультифора
- Зажимы для бумаг
- Клей-карандаш
- Калькуляторы
- Канцелярские ножи
- Скрепки
- Кнопки
- Степлеры и антистеплеры
- Другие канцтовары для переплета и скрепления
- Резаки для бумаги
- Другие канцтовары
- Диспенсеры для ленты
- Ножницы
- Свисток, дудки,тату наклейки
- Свисток
- Веселый оратор
- Поддержка баннера
- Поддерживать свет Карта
- Акробатика
- Сценический спектакль магический реквизит
- Тату наклейки
- Расходные материалы
- Система непрерывной подачи чернил
- Термотрансферные ленты
- Пленки для фотоаппарата
- Лазерные диски для записи
- Тонеры для картриджей
- Дискеты и аудиокассеты
- Барабан для принтера
- Другие расходные материалы
- Чернила для принтеров
- Картридж с тонером
- Творческие подарки
- Творческая наклейка
- Отмена(обращаться низ Линия, не отправляйте продукты)
- Творческие подарки комплект
- Творческие светильники
- День рождения
- Подарочная карта
- Золотая фольга
- Солнечный банки/Лунный свет банки
- Счастливая кошка
- Подставка под телефон
- Ремесло
- Счастливая бутылка
- Ньютон
- Песочные часы
- Ракушки/коралл
- Отпечаток рук
- Подарочные коробки
- Письменные принадлежности
- Мелки
- Гелевые ручки
- Маркеры
- Карандаши
- Шариковые ручки
- Каллиграфические ручки
- Текстовыделители
- Аксессуары для ручек
- Стержни для ручек
- Подарочные и необычные ручки
- Шариковые ручки класса люкс
- Другие ручки
- Маркер
- Автоматические карандаши
- Маркеры для досок
- Чернила для перьевых ручек
- Ручки на подставке
- Фломастеры
- Разные ручки
- Перьевые ручки для макания в чернила
- Искусственные цветы, растения и деревья
- Искусственные цветы
- Искусственные листья и деревья
- Искусственная лоза
- Искусственные растения
- Подарочные коробки с цветами
- Шелковый цветок
- Искусственный газон
- Искусственные розы
- Искусственные фрукты
- Искусственные растения в аквариумы
- Аксессуары для искусственных растений
- Искусственный папоротник
- Мыло
- Копия Настоящие лепестки
- Искусственные растения в горшках
- Разные цветы
- Товары для праздников
- LED свечи
- Цветные яйца
- Свечи
- Аксессуары для воздушных шаров
- Праздничные украшения для интерьера
- Воздушные шары
- Подсвечники
- Реквизиты для маскарадов и праздников
- Цветы для украшения
- Свистки, светящийся реквизит
- Карнавальные маски
- Колокольчик
- Новогодние украшения
- Насосы для воздушных шаров
- Снег в баллончиках
- Треугольные флажки
- Светящиеся ободки и шляпы
- Декорации
- Копия Настоящие книжные ремесла
- Лафит
- Пузырь/шарики
- Флуоресценция
- Офисное оборудование
- Лазерные принтеры
- Гравировальный станок
- Сканеры штрих кода
- Другое офисное оборудование
- Запчасти и аксессуары для проекторов
- МФУ
- Проекторы
- Запчасти и аксессуары для принтеров
- Струйные принтеры
- Шредеры
- Струйные широкоформатные принтеры
- Термопринтеры для чеков и фото
- Расходные материалы для 3D печати
- Принтеры штрих кода
- Сенсорные экраны
- Подвесные крепления для проекторов
- Другое оборудование для офиса, обучения и проведения мероприятий
- Лазерная указка
- Сейфы
- Телефоны для конференций
- Офисные стационарные телефоны
- Аксессуары для проекторов ручной работы
- Лампочки и свет для проектора
- Наборы для подключения проекторов
- Карт принтеры
- Другое торговое оборудование
- Аксессуары для сканеров штрих кодов
- Переплетчики (брошюровщики)
- Офсетная печатная машина
- Видеодомофоны
- Машины контроля посещаемости
- Термопринтеры
- Матричные принтеры
- Пленочные проекторы
- Копировальная техника
- Планшеты для письма и рисования
- Сканеры
- Экраны для проектора
- Сканеры штрих кодов
- Сканеры QR-кодов
- Получать стиль машина
- Сканеры с памятью
- Сканеры для сбора данных
- Сканеры Paiyi
- Картриджи для струйных принтеров
- Широкоформатные принтеры
- Сублимационные фотопринтеры
- Другие принтеры
- Счетчики купюр
- Аксессуары для счетчиков денег
- Портативные устройства проверки купюр
- Интерактивные панели
- Аксессуары для сканеров
- Зеркала и линзы для проекторов
- Кронштейны для проекторов
- Дистанционное управление для проекторов
- Резак для бумаги
- Факсы
- Система видеоконференции
- Плоттеры
- Ламинаторы
- Цифровые проекторы
- Проекторы
- Оптовые продажи офисных канцтоваров
- Совместное производство офисных канцтоваров
- Совместное производство офисных канцтоваров
- Магический свет машина
- Прокрутить машину
- Всё для рисования и каллиграфии
- Палитра
- Принадлежности для каллиграфии
- Написание воды
- Масляные краски
- Кисти для рисования
- Художественная краска
- Другие принадлежности для рисования
- Линейки
- Бумага и холсты
- Акварельные и пастельные мелки, карандаши
- Аксессуары для рисования
- Другие канцтовары черчения и рисования
- Аксессуары для скрепления листов
- Мелки
- Мольберты и подставки
- Трафареты
- Рамки
- Кисти для каллиграфии
- Блокнот для рисования, Эскиз
- Держатели для ручек и кистей
- Статуя из гипса
- Музыкальные инструменты
- Гитара, укулели и др
- Аксессуары для музыкальных инструментов
- Другие музыкальные инструменты
- Ударные музыкальные инструменты
- Духовые инструменты
- Клавишные музыкальные инструменты
- Детские музыкальные инструменты
- Струнные инструменты
- Магнитно-маркерные и меловые доски
- Бейджики и шнуры для них
- Белые доски
- Другие демонстрационные аксессуары
- Учебное пособие
- Магнитные доски
- Демонстрационное оборудование
- Черные меловые доски
- Зеленые меловые доски
- Губки-стиратели
- Магнитные держатели для досок
- Фирменные липучки и наклейки
- Стенды для шоурумов и промо
- Флуоресценция панель
- Панель
- Бумажная продукция
- Блокноты и ежедневники
- Блокноты для заметок
- Стикеры
- Сменные блоки в ежедневники и тетради на кольцах
- Блокноты и тетради на пружинах
- Конверты и бумага для писем
- Другие тетради, блокноты и ежедневники
- Тетради и блокноты в мягкой обложке
- Телефонные книжки
- Ежедневники и бизнес-тетради
- Наклейки для ручной маркировки
- Выпускные альбомы
- Открытки, наклейки
- Настольные календари
- Поздравительные открытки
- Открытки
- Календари
- Аниме
- Наклейка
- Звездный плакат/фото
- Коллекция произведений искусства
- Ручка
- Плита
- Творческая печать/печатная грязь
- Материалы вокруг руководства
- Держать клип
- Справочник
- Справочник
- Руководящая модель рисования панель
- Справочник по перчатке
- Застрял кирпич
- Наклейка/лента по справочнику
- Творческая наклейка
- Декоративные скотчи и клейкие ленты
- Справочник печати
- Справочник
- Ручка комплект
- Ремесло
- Покидать(обращаться низ Проволока)
- (обращаться низ Линия, не отправляйте продукты)
- Текущая вода
- Городское украшение
- Открытие/украшение внутреннего двора
- Камни
- Фенг Шуи мяч
- Резьба по лесу/корне
- Другое украшение
- Ремесло
- Том 2(обращаться низ Линия, не отправляйте продукты)
- Гипс, каменные ремесла
- Металлический Ремесло
- Деревянное судно
- Смоловые ремесла
- Бумажное судно
- Керамические ремесла
- Пластиковые ремесла
- Другие материальные ремесла
- Стеклянные изделия
- Ботанические ремесла
- Джемные поделки
- Хрустальные ремесла
- Благосная горелка
- Бамбуковые качественные ремесла
- Клиняная скульптура ремесло
- Нефритовые произведения
- Меховое судно
- Застекленные поделки
- Декоративный меч
- Угольный ремесленник
- Реклам для резьбы для костей/стоматологических ремесел
- Вышивка и вышивающие ремесла
- Железная живопись
- Лакированные ремесла
- Jingtai синий (Эмалевая посуда)
- Мягкое глиняное мастерство
- Ремесло поколение Присоединиться
- Вельверы и золотые поделки
- Копия Нефритовое ремесло
- Zisha Craft
- Медная резьба
- Стандартный Книга
- Сянгьяо/Сяньгьин
- Craft Gift Project Coperation
-
Косметика и уход за кожей
- Для ГУБ
- Губные помады
- Блеск для губ
- Блеск для губ
- Блеск для губ
- Карандаши для губ
- Массажер из нефрита
- Уход за глазами
- Уход за кожей вокруг глаз
- Крем воркуг глаз
- Eye Essence
- Уход за кожей вокруг глаз
- Уход за губами
- Увлажнение для губ
- Средства для питания и восстановления губ
- Бальзамы и масла для губ
- Другие средства для ухода за губами
- Детская защита для губ
- Уход-комплект ждя губ
- Гель для губ
- Мужская косметика
- Мужские тоники и тонеры
- Увлажняющие лосьоны для мужчин
- Мужской крем для лица
- Мужской крем для тела
- Кремы для бороды
- Мужские средства для очистки кожи
- Мужские маски для лица
- Наборы для ухода за лицом мужские
- Мужские бальзамы для губ
- Уход за кожей вокруг глаз для мужчин
- Красота и ежедневная обработка
- Уход за кожей вокруг глаз
- Ароматерапия, эфирные масла
- Инструмент для макияжа
- Макияж
- Маска для лица
- Уход за лицом
- Обработки кожи
- Обработка для ногтей
- Уход за телом
- Эфирное масло
- Эфирное масло комплект
- Эфирные масла
- Гидролаты
- Масла для тела
- Мыло с эфирным маслом
- Масло для лица
- Другие продукты ароматерапии эфирного масла
- Уход за лицом
- Зона носа
- Крема для лица
- Наборы для ухода за лицом
- Очищающая продукция
- Кислотные пилинги
- Лосьоны и тонеры
- От черных точек
- Солнцезащитные средства
- Мыло ручной работы
- Алое
- Средства для снятия макияжа
- Гель, мазь
- Крем для массажа лица
- Детские Эмульсия/крем
- Черный Главный гид
- Детские Стрезивное молоко
- Другие продукты по уходу за кожей
- Детские Солнцезащитный крем/экспозиция
- Декоративная косметика
- BB-крем
- Тональная основа
- Карандаши консилеры
- Румяна
- Консилеры
- Палетки для макияжа
- Компактные пудры
- Другая декоративная косметика
- Рассыпчатые пудры
- Тональник
- Хайлайтер
- Фиксатор макияжа
- Макияж для глаз
- Карандаши и тени для бровей
- Тени для век
- Подводки для глаз
- Тушь для ресниц
- Маска для лица
- Маска
- Маска для лица комплект
- Увлажняющие маски
- Крем маска
- Духи
- Нейтральный парфюм
- Другие духи
- Духи
- Духи
- Твердый
- Инструменты для макияжа и косметического ухода
- Кисточка
- Наборы кистей для макияжа
- Расчески для волос
- Накладные ресницы
- Другие инструменты для макияжа и ухода
- Спонжи для макияжа
- Ватные палочки и диски
- Инструменты для ресниц
- Тканевые маски и инструменты для замешивания сухих масок
- Ватные палочки
- Инструменты для бровей
- Бигуди
- Инструменты для макияжа
- Клей для двойного века
- Инструменты для чистки пор и прыщей
- Для умывания
- Парикмахерские ножницы
- Средство для снятия макияжа, салфетки
- Матирующие салфетки
- Пинцет для накладных ресниц
- Патч Акне
- Ватные палочки
- Щетка для ресниц
- Бровь
- Маникюрные ножницы
- Трафарет для бровей
- Тушь для ресниц Cashblite
- Раствор для чистки
- Средства и инструменты для ногтей
- Наклейки и украшения для ногтей
- Другие инструменты для ногтей
- Маникюрные наборы
- Кусачки для ногтей
- Пилки для ногтей
- Ультрафиолетовые лампы для наращивания ногтей и гель-лака
- Накладные ногти
- Гель-лаки для ногтей
- Ножницы и кусачки для ногтей
- Укрепляющие средства для ногтей
- Инструменты для наращивания ногтей и ногтевого дизайна
- Наклейки для ногтей
- Кисти для сметания пыли с ногтей
- Средства для снятия лака
- Косметический инструмент
- Массажеры для лица
- Татуировка, набор инструментов
- Инструменты для подтяжки лица
-
Домашние животные и садоводство
- Цветочные горшки и вазы
- Цветочные горшки, для рассады
- Ваза
- Бутылки и ёмкости для создания экосистемы
- Декоративные цветочные горшки
- Колбы и бутылки для композиций из растений
- Декорация, пейзаж
- Товары для собак и кошек
- Намордник
- Лежаки и клетки для собак
- Миски и поилки для собак
- Ошейники, поводки, шлейки для собак
- Игрушки для кошек
- Игрушки для собак
- Клетки, домики и лежаки для кошек
- Сумки и чемоданы для перевозки собак
- Миски и поилки для кошек
- Сумки и чемоданы для перевозки кошек
- Коляска для домашних животных
- Ведро для хранения корма
- Стойка для кошки
- Поводки, ошейники и шлейки для кошек
- Ультразвуковой отпугиватель
- Чесать когти
- Мелкие домашние животные и уход за ними
- Клетки и домики для хомяков
- Обустройство клетки для хомяков
- Корм для птиц
- Клетки и гнезда для кроликов
- Другие аксессуары для мелких животных
- Товары для кроликиков
- Хомячки
- Шиншиллы
- Аксессуары для птиц
- Другие мелкие животные
- Корм для кролика
- Клетки для птиц
- Зерновые смеси для грызунов
- Вкусняшки для грызунов
- Игрушки для хомяков
- Средства для ухода за грызунами
- Зерновые смеси для шиншиллы
- Вкусняшки для шиншиллы
- Обустройство клетки для шиншиллы
- Средства для ухода за шиншиллами
- Клетки и домики для шиншиллы
- Умные устройства для животных
- ПЭТ Умное кормление оборудование
- Smart-ошейники
- Умный кошачий туалет
- Очиститель воздуха
- Уборка и уход за домашними животными
- Освежитель воздуха
- Спрей для приучения к туалету
- Щетки, расчески и кусачки для ногтей
- Кошачий туалет
- Удаление шерсти
- Сумка для сбора отходов животных
- Подгузник, пеленка для домашних животных
- Лечение уха
- Оральная очистка
- Щетки, расчески и кусачки для ногтей
- Косметический стол
- Средства для мытья собак
- Очистка глаз
- Совки для улицы
- Спрей для обозначения запретных территорий
- Лопатка для кошачьего туалета
- Собачий туалет
- Ванна/грумминг
- Увлажняющий крем для лап
- Домашний фен
- Гамак для ухода за домашними животными
- Ящик для сушки домашних животных
- Средства для мытья кошек
- Кусачки для ногтей
- Триммер для животных
- Колтунорез
- Аквариумы и рыбки
- Аксессуары для аквариума
- Оборудование для стерилизации
- Камни и песок для аквариумов
- Другие аксессуары для аквариумов
- Аквариумы
- Погружной насос для аквариумов
- Украшения для аквариума
- Компрессоры для аквариумов
- Корм для рыбок
- Инструменты для чистки аквариумов
- Освещение для аквариумов
- Фильтры для аквариумов
- Термостаты для аквариумов
- Термометры для аквариумов
- Переносные аквариумы
- Кормушки для аквариумов
- Таймеры для аквариумов
- Контроль PH для аквариумов
- Инкубатор
- Одежда для домашних животных, аксессуары
- Шапка для домашнего питомца
- Подвеска
- Носки для домашних животных
- Сумка для питомцев
- Аксессуары для шерсти
- Одежда для собак
- Ошейник
- Одежда для кошек
- Обувь для собак
- Защитный воротник
- Шарф для домашнего питомеца
- Стерилизация домашних животных/физиологические штаны
- Садовые инструменты
- Садовые инструменты
- Полив и орошение
- Другие садовые принадлежности и инструменты
- Другие товары для животных
- Решетки и ограждения
- Ошейники с GPS навигаторами
- Урна для похорон
- Принадлежности для дрессировки
- Другие принадлежности для ухода за животными
-
Автомобильные аксессуары
- Электрооборудование в салон авто
- Манометры для шин
- Автомобильные массажеры
- Другие электроустройства для авто
- Компрессоры, воздушные насосы
- Портативные холодильники
- Автомобильные пылесосы
- Автомобильные зарядные устройства
- Кислород-бары и очистители воздуха
- Автомобильный прикуриватель
- Автомобильный кондиционер обогреватель
- Навигация и звук
- Авто Телевизор, Монитор
- Hands-free для автомобиля
- Магнитолла, автомобильный плеер
- Авто магнитафон андройд
- Рация для автомобиля
- Автомобильный дисплей
- Автомобильная GPS навигация
- Консоль, монитор
- Проигрыватель MP5
- Smart-зеркало заднего вида
- CD проигрыватели
- FM передатчики
- Другие средства связи для авто
- Видеорегистраторы
- Автозвук
- GPS-локатор
- Автомобильные камеры
- DVD проигрыватель
- Другие аудио- видео- аксессуары для автомобиля
- Датчики парковки
- MP3 проигрыватели
- Авто монитор
- MP4 проигрыватели
- Мотоцикл. Рекордер
- Чехлы, коврики и подушки в салон
- Четырехсезонные чехлы и коврики на сидения
- Чехлы на сидения для конкретных марок авто
- Разные коврики в авто
- Мягкие коврики в багажник
- Коврики с ворсом в авто
- Многофункциональная подушка на сидение
- Чехлы и подушки на сидения
- Мягкие коврики в салон
- Подушки на сидения
- Пуховые и меховые чехлы на сидения в авто
- Коврики в багажник
- Летние и охлаждающие чехлы и подушки на сидения
- Мото аксессуары
- Мотоциклетный шлем
- Мотоциклетный багажник, бокс
- Украшения для шлема
- Мотоциклетные фары
- Мотоцикл переднее ветровое стекло
- Мотоциклетные ручки
- Трансмиссии мотоциклов
- Мотоциклетные гудки
- Защита от грязи, крыло
- Мотоциклетный шлем анти -ффо -пленка
- Ключи, балванки для мото
- Седло для мотоцикла
- Замки, личинки, ключи
- Рамка для номеров
- Гарнитура для шлема
- Выхлопная труба
- Накладки на педали
- Мотоциклетное колесо
- Карбюратор для мото
- Защита рамы мотоцикла
- Мотоцикл детские Сиденье
- Зеркало заднего вида мото
- разные товары для мото
- Аксессуары для шлема мотоцикла
- Рулевое управление мотоциклов
- Мотоцикл хвост крыло
- Запчасти ходовой части мотоцикла
- Мотоциклевая рама
- Запчасти для мотоциклов
- Мотоциклетные принадлежности и аксессуары
- Двигатель для мотоцикла
- Электрооборудование и приборы для мотоциклов
- Шины, резина
- Шины и камеры для авто
- Автошины, резина
- Аксессуары для салона авто
- Автомобильные термометры
- Защитная пленка в салон автомобиля
- Ручка на руль
- Чехлы и держатели для CD-дисков
- Другие аксессуары для интерьера авто
- Украшения и фигурки в авто на панель
- Ящики и мешки для хранения в авто
- Занавесы, чехлы от солнца
- Автомобильные пороги
- Автомобильные духи, вонючки в салон
- Нескользящие коврики на панель и подложки под телефон
- Подушки под поясницу
- Подушки на ремень безопасности
- Мягкие оплетки руля
- Подвесные украшения в авто
- Подголовники и подушки под спину
- Держатель телефона
- Автомобильный подлокотник
- Номер телефона, временная парковка
- Шторки и занавесы для авто
- Держатели для напитков
- Ключницы, брелки, чехлы
- Держатель для очков и бумаги
- Автомобильные пепельницы
- Автомобильная надувная кровать, матрац
- Автомобильные держатели и органайзеры
- Чехлы на ручник и рычаг КП
- Духи и благовония в авто
- Антистатический, силиконовый брелок
- Автомобильный компас
- Угольные очистители воздуха
- Подушка подлокотника
- Защита заднего сидения, Back -Back Kick Pad
- Защита на панель - торпеду
- Затенение панель зеркало заднего вида
- Автомобильный столик
- Средства для ухода за автомобилем
- Присадки в моторное масло
- Присадки в бензин
- Моторные масла
- Автомобильный хладагент
- Инструменты для чистки авто
- Средства для стекол
- Чистящее средство для автомобиля
- Автомобильный воск
- Автомобильные краски и эмали
- Портативные автомойки
- Оборудование для мойки авто
- Другая автокосметика
- Стеклоочиститель
- Водяной пистолет для мойки авто
- Ремонт автомобильного стекла
- Корректор краски
- Тормозная жидкость
- Дизельное моторное масло
- Защита поверхности: пленки и скотчи
- Автомобильный воздушный охлаждающий агент
- Очистка автомобиля мягкий клей
- Свет и фары
- Ксеноновая лампа HID
- Лампочки в фары
- Другие виды освещения для авто
- Противотуманные фары
- Светильники для ремонта авто
- Лампочки для авто
- Задние фонари, стопы, лампочки
- Светодиодная лента
- Дневной свет
- Подсветка на крышу
- Лампочки в стоп-сигналы
- Светодиодные лампы T10
- Мотоциклетные фары
- Подсветка номерного знака
- Внешний тюнинг и аксессуары для автомобиля
- Отделка дверных ручек
- Тюнинг крышки бака
- Звукоизоляционный материал
- Автомобильные наклейки
- Другие аксессуары для тюнинга авто
- Защитные полоски на бамперы
- Чехол на автомобиль
- Другие аксессуары для тюнинга иномарок
- Круглое зеркало заднего вида
- Люки для авто
- Спойлеры и антикрылья
- Ветровики
- Зеркало заднего вида, козырьки, наклейки
- Всё для тюнинга бампера
- Брызговики, фэндеры
- Обвесы
- Колпаки на колеса
- Автомобильная пленка
- Отделка для окон авто
- Тюнинг оптики
- Блоки розжига для ксеноновых ламп
- Светодиодная лента
- Боковые фендеры
- Тюнинг оптики
- Чехлы на запасные колеса
- Маскитные сетки
- Накладки на тормоза
- Велосипедный багажник
- Значок автомобиля
- Защита от снега, чехол
- Электромобили
- Экскурсионные автомобили
- Электрические велосипеды
- Другие электромобили
- Электрические трехколесные велосипеды
- Электромотоциклы
- Электромобили
- Электрический поколение Ходить
- Электрический проскальзывание панель машина
-
Аксессуары
- Маски для лица, теплые наушники
- Маски для лица
- Теплые наушники
- Аксессуары сделанные на заказ
- Аксессуары для одежды
- Подтяжки
- Сделай сам, аксессуары для одежды
- Аксессуары для одежды ночного клуба
- Кольца, браслеты
- Карманные платочки
- Запонки
- Аксессуар, косплей
- Военные аксессуары
- Подъюбники
- Аксессуары для свадебной одежды
- Аксессуары для фестиваля
- Аксессуары для танца, гимнастики
- Коррекция фигуры
- Нашивки и повязки
- Наколенники
- Разное
- Шарфы-косынки на голову
- Головные уборы
- Аксессуары для шляп и кепок
- Головные уборы униформа
- Балаклава
- Шапка с капюшоном
- Фестивальные головные уборы
- Религиозные головные уборы
- Аксессуары для ювелиров
- Цепочки
- Нитки, веревочки
- Набор инструментов
- Аксессуары для волос, аксессуары для головных уборов
- Серьги, аксессуары к ним
- Аксессуары с застежкой
- Другие ювелирные аксессуары
- Подвеска/кулон
- Бусины
- Ювелирные изделия
- Булавки, стрелки
- Аксессуар
- Кулон, брелок
- Страза
- Синтетические/искусственные украшения
- Синтетическое/культивирование украшения алмаза
- Синтетическое/культивирование алмазного кольца
- Синтез/выращивание алмазных обнаженных камней
- Синтетическое/выращивание бриллиантов
- Синтетические/культивирующие алмазные серьги
- Естественные украшения
- Цепочки
- Натуральный хрустальный камень
- Украшения агата
- Кристаллическое кольцо
- Хрустальный браслет
- Украшения
- Агат
- Кольцо агата
- Агатовые серьги
- Агат
- Натуральный кристалл Эррин
- Аксессуары для украшений
- Наборы ювелирных украшений
- Перчатки, нарукавники
- Разные перчатки
- Свадебные перчатки
- Теплые перчатки для взрослых
- Перчатки, УФ-защита
- Нарукавники, УФ-защита
- Нарукавники
- Подставки для хранения аксессуаров
- Браслеты и кольца
- Перстни, кольца
- Браслеты
- Браслеты и напульсники
- Браслеты-кольца
- Кольца
- Четки
- Ремешок на руку
- Одноразовый браслет
- Цепочки на тело
- Наручные часы и обслуживание
- Часовой механизм
- Детские наручные часы
- Карманные часы
- Корпусы для наручных часов
- Стеклышки для часов
- Стрелки и заводные механизмы
- Часы, сделанные на заказ
- Светящиеся часы
- Циферблаты
- Часы с радио
- Кварцевые часы
- Электронные часы
- Механические часы
- Ремешки для часов
- Задние крышки от наручных часов
- Другие инструменты для ремонта часов
- Подарочные коробочки и упаковка для часов
- Гаечки для завода часов
- Другие часы
- Инструмент для часов
- Аксессуары для волос
- Фата и вуали
- Липучки для волос, украшения на липучках
- Заколки и подкладки для объемной прически
- Резинки для волос
- Ободки
- Шпильки
- Повязка на голову
- Заколки и крабики
- Резинки для греческой прически
- Шпилька длинная
- Приспособления для создания причесок
- Разное
- Другие аксессуары для волос
- Гребни
- Цепочка для волос
- Сеточка для волос
- Шпильки и палочки для волос
- Цветок на голову
- Диадема
- Гребни для украшения волос
- Будда бусинки/четки
- Очки и аксессуары
- 3D очки
- Специальные защитные очки
- Чехлы и футляры для очков
- Пати очки
- Очки солнцезащитные
- Оправы очков
- Очки с диоптрией
- Детские очки
- Цепочка для очков
- Салфетки тканевые для протирания очков
- Разные очки
- Линзы для очков
- Оптика
- Нескользящие душки на нос
- Другие очки и аксессуары
- Оправы детских очков
- Средство для чистки очков
- Компьютерные очки
- Проверка зрения
- Аксессуары для ремонта очков
- Оборудование и аксессуары
- Очки, сделанные на заказ
- Подвески
- Ожерелья
- Подвески
- Разные подвески
- Чокеры, ошейники
- Шарфы и платки
- Плащ
- Солнцезащитная вуаль, поверхность солнцезащитного крема накладка
- Тонкие шарфики и накидки
- Легкий шарфик
- Шаль
- Зимние шарф -хомут
- Другие шарфы платки балаклавы
- Солнцезащитный крем
- Шарфы, шали и платки
- Лента
- Талия
- Детские аксессуары
- Детские Аксессуары для волос
- Детские Ювелирные изделия
- Детские элементы украшений
- Другие детские Аксессуары
- Детские Украшение ног
- Детские серьги
- Наборы из шапок, шарфов и перчаток
- Наборы: шарфы и перчатки
- Наборы: теплые маски и наушники
- Наборы из шапки и шарфа
- Наборы: шапки, шарфы и перчатки
- Другие шапки
- Ремни и пояса
- Застежка, бляшка на ремень
- Кожаные ремни
- Бижутерия для талии
- Украшения и цепи на талию
- Аксессуары для ремней и поясов
- Пояса для похудения и бандажи
- Широкие ремни и пояса
- Другие украшения
- Пирсинг в пупок
- Украшения для ног
- Другие ювелирные изделия
- Прочие украшения
- Украшения на одежду
- Бутоньерки
- Другие украшения
- Украшение на воротник рубашки
- Брош
- Длинные цепочки
- Длинные ожерелья и массивные подвески
- Шарф с застежкой
- Аксессуары для воротника, галстуки, бабочки
- Фальшивый воротник
- Галстуки
- Женские галстуки и бабочки
- Галстук-бабочка
- Зажимы для галстука
- Серьги
- Серьги Гвоздики
- Серьги Колечки
- Висячие серьги
- Серьги с застежкой
- Клипсы
- Серьги на цепочке
- Серьги на крючке
- Серьги
- Пирсинг
- Другие украшения для пирсинга
- Auriculum
- Пирсинг в нос
- Пирсинг для губ
- Пирсинг в язык
- Принадлежности для шоурумов
- Мебель для шоурумов
- Стойки для одежды
- Манекены
- Ярлыки с размерами для вешалок
- Вешалки для брюк
- Плечики и вешалки
- Другие аксессуары для шоурумов
- Ювелирные изделия и аксессуары
- Золотые браслеты и кольца с указанием пробы
- Другие украшения из природного жемчуга
- Серьги с драгоценными камнями
- Браслеты и кольца с драгоценными камнями
- Наборы украшений из натурального жемчуга
- Серьги с натуральным жемчугом
- Другие украшения с драгоценными камнями
- Золотые серьги с указанием пробы
- Браслеты и кольца из натурального жемчуга
- Другие украшения из натурального нефрита
- Браслеты и кольца из натурального нефрита
- Ювелирные изделия, сделанные на заказ
- Серьги с бриллиантами
- Золотые серьги
- Браслеты и кольца с бриллиантами
- Золотые браслеты и кольца
- Золотые броши с указанием пробы
- Реплики колец с бриллиантами
- Бусы и подвески из натурального жемчуга
- Наборы золотых украшений с указанием пробы
- Бусы и подвески с драгоценными камнями
- Украшения для волос из натурального нефрита
- Наборы украшений с изумрудом
- Наборы украшений с драгоценными камнями
- Броши с драгоценными камнями
- Броши из натурального жемчуга
- Другие украшения с изумрудом
- Браслеты и кольца из нефрита уезда Хотан
- Браслеты и кольца из янтаря
- Браслеты и кольца с изумрудом
- Серьги из натурального нефрита
- Другие украшения из нефрита уезда Хотан
- Золотые цепочки и подвески с указанием пробы
- Наборы украшений из янтаря
- Браслеты и кольца из платины
- Наборы из платины
- Наборы украшений с бриллиантами
- Серьги с изумрудом
- Бусы и подвески из нефрита уезда Хотан
- Серьги из платины
- Серьги с янтарем
- Золотые цепочки и подвески
- Бусы и подвески с изумрудом
- Другие золотые украшения
- Реплики сережек с бриллиантами
- Хитиан Джейд висит
- Золотые украшения на щиколотку
- Другие украшения с бриллиантами
- Другие золотые украшения с указанием пробы
- Золотые броши
- Наборы золотых украшений
- Другое дорого металлический аксессуары
- Реплики других украшений
- Реплики украшений для волос с бриллиантами
- Другие реплики украшений
- Золотые украшения для ног с указанием пробы
- Цепочки и подвески из платины
- Броши из платины
- Другие украшения из платины
- Бусы и подвески с бриллиантами
- Броши с бриллиантами
- Бусы и подвески из натурального нефрита
- Наборы украшений из натурального нефрита
- Бусы и подвески из янтаря
- Другие украшения из янтаря
- Одежда, сделанная на заказ
- Разное
- Проект одежды
-
Мобильная электроника
- Аксессуары для Apple
- Чехол для гарнитуры (наушников)
- Чехлы для iPhone
- Защитные чехлы для Macbook
- Чехлы на AppleWatch
- Ремешок для AppleWatch
- Защитная пленка на iPhone
- Чехлы для iPad
- Пленка на экран AppleWatch
- Защитная крышка/оболочка Airtag
- Защитная пленка для Macbook
- Защитная пленка на iPad
- Другие аксессуары для Apple
- Серия Apple комплект
- Smart электроника
- Smart-очки
- Дата-кабели
- Зарядные устройства
- Карманные переводчики
- Интеллектуальные роботы
- Проекторы с колонками
- Мониторинг безопасности, камеры
- Обучающие роботы для детей
- Smart-часы
- Переходники и розетки с функцией отключения
- Smart-браслет
- Ремешки для smart-часов
- Аксессуары для smart-устройств
- Сетевое оборудование, роутер
- Дистанционное управление, пульт
- Наушники
- Удлинители с USB портами
- Брелоки для поиска вещей
- Шагомеры
- Smart-кольцо
- Smart-часы для пожилых
- Клипсы для устройств
- Стеклышки для smart-часов
- Детские smart-часы
- VR-очки
- Роутеры и маршрутизаторы
- Многофункциональные телефоны
- Веб-камеры
- Smart-браслет
- Трекеры
- Smart-подвеска
- Вибромассажеры
- Smart-повязка на голову
- Smart-портмоне
- Наклейки и закладки с датчиками
- Интеллектуальные маски для сна
- Тестеры кожи
- Веб-камеры
- Устройства Smart Touch
- Интеллектуальные аксессуары для мониторинга безопасности
- Интеллектуальная сигнализация
- Корпуса для smart-часов
- Ремешки для smart-браслетов
- 4g устройство
- Другие интеллектуальные устройства
- Интеллектуальные глюкометры, тонометры и измерители показаний
- Компьютерные комплектующие и аксессуары
- Серверные аксессуары
- Оптический приводы, рекордеры
- Другие провода для компьютеров
- Другие мониторы
- Жесткие диски SSD
- Провода и кабели для ПК
- Видеокарты
- Радиаторы
- Материнские платы
- Жидкокристаллический монитор
- Другие компьютерные аксессуары
- Корпуса для ПК
- Блоки питания
- Процессоры
- Плашки памяти
- Звуковые карты
- Жесткие диски HDD
- ЭЛТ монитор
- Флоппи-дисководы
- Источники бесперебойного питания
- Дисковый массив
- Аксессуары для мобильных телефонов
- Коврики для мобильного телефона
- Стикеры на телефоны
- Другие аксессуары для мобильных телефонов
- Подвески для мобильного телефона
- Кармашки и чехлы для ношения телефона
- Ремешки для мобильного телефона
- Полировки экрана
- Держатели мобильного телефона
- Аксессуары для техники
- Защитный чехол для игровой приставки
- Зарядные устройства для игровых приставок
- Рулевое колесо для приставок
- Цифровой видеокабель
- Riser-карта, патч-корд, перехожник
- Другие цифровые аксессуары
- Наушники
- Джойстики и контроллеры к игровым приставкам
- Цифровая карта памяти
- Адаптеры зарядных устройств
- USB-концентраторы
- Держатели и скрепки для проводов и наушников
- Мобильные жесткие диски
- Цифровой аудиокабель
- Картридеры
- Цифровой шнур питания
- Цифровые очки
- Цифровые антенны
- Кабель HDMI
- Внешние CD приводы
- Цифровые зарядные устройства
- ТВ-тюнеры
- Видеокарта, перходник
- Защитная пленка для игровой приставки
- Другие цифровые провода
- Чистка гарнитуры
- E -Book защитный корпус
- Карта игровой машины
- Другие аксессуары для игровых приставок
- Цифровые разъемы
- Игровой рокер
- Чехлы и корпуса
- Цифровые наборы аксессуаров в дорогу
- Фотоаппараты и аксессуары
- Камеры для домашних животных, фотоловушка
- Маска для глазной камеры
- Цифровые видео-камеры
- Фото лампа
- Цифровые камеры со сменной оптикой
- Камеры для подводной съемки
- Компьютер для дайвинга
- Аксессуары для подводной съемки
- Видоискатель, телескоп
- Светофильтры для объективов
- Чехлы для объектива
- Аккумуляторы
- Чистящие средства для камеры
- Крышки объектива камеры
- Аксессуары GoPro
- Защитные пленки на экран фотоаппарата
- Объективы для камер
- Другие аксессуары для фотоаппаратов
- Polaroid
- Селфи-палки
- Зеркальные камеры
- Плавучий держатель экшн-камеры
- Аксессуары для фото дайвинга
- Переходные кольца и адаптеры
- Чехлы и сумки для фототехники
- Бленда
- Аксессуары для экшн-камер
- Фон для съемки
- Кабель питания камеры
- Водонепроницаемые чехлы для камер
- Мини-камеры
- Экшн-камеры
- Вспышки
- Освещение для съемки
- Оборудование для фотосъемки
- Шарнирные держатели для фотоаппаратов
- Лайтбоксы
- Штативы
- Цифровые фото-камеры
- Стойки для освещения
- Штативы для фотоаппаратов
- Свет
- Батарейная рукоятка
- Наружное фотооборудование
- Ремешки для камеры, браслеты
- Зарядное устройство для камеры
- Стикеры для корпуса камеры
- Живой телевизор
- Спуск затвора камеры
- Видоискатели
- Цифровые устройства
- Самолет
- Цифровые фоторамки
- VR/AR All -IN -One Game Console
- Соматосенсорные игровые консоли и приставки
- Портативные DVD
- Электронные книги
- Игровая консоль симулятора
- MP4 проигрыватели
- MP3 проигрыватели
- USB флешки
- Мобильный жесткий диск
- КПК
- Цифровые камеры
- Другие цифровые устройства
- Игровые консоли
- Сетевые модэмы
- 3D-цифровые очки
- Диктофоны
- Ручные игровые консоли
- Цифровые устройства
- Компьютерные периферийные устройства
- Компьютерный сетевой кабель
- Компьютерный сетевой кабель
- Беспроводные мыши и клавиатуры
- Наушники
- Клавиатура
- Кнопки с клавиатуры
- E -Sports Периферийно
- Подставка под гарнитуру
- Клавианые аксессуары
- Подставка под клавиатуру
- Колонки для компьютера
- Наклейки для мышки
- Защитный экран
- Радиационная защита
- Коннекторы
- Клавиатуры
- Коврики для мышек
- Оптические мышки
- Чистящие средства для компьютеров
- Наборы клавиатуры и мыши
- Компьютерный стенд
- Другие принадлежности, связанные с компьютером
- USB коврики для мышки с подогревом
- Другие мышки, клавиатуры
- Игровые мышки
- Аксессуары для ноутбуков
- Защитная пленка для клавиатуры ноутбука
- Клавиатуры для ноутбука
- Защита ноутбука
- Защитные пленки для ноутбуков
- Пленки на корпус ноутбука
- Блок питания для ноутбука
- Кулеры для ноутбуков, ветиляторы
- Наклейки для ноутбуков
- Аккумуляторы для ноутбука
- Аксессуары для планшетов
- Дата-кабели
- Зарядные устройства
- Чехлы для планшетов
- Внешние клавиатуры
- Держатели для планшетов
- Защитные пленки для планшета
- Другие аксессуары для планшетов
- Аксессуары
- Штатив для устройств
- Субтитры
- Устройства для звука
- Компьютеры, ноутбуки, планшеты
- Моноблоки
- Мини-компьютеры
- Нетбуки, ультрабуки
- Рекламные экраны
- Мониторы
- Терминалы и справочные экраны
- Сенсорные экраны
- Планшеты
- Сервера, рабочие станции
- ПК
- Мини-ПК
- Цифровое промышленное оборудование системы управления
- Другое серверное оборудование
- Промо-экраны с тачпадом
- Ноутбуки
- Промышленные компьютерные продукты
- Мобильные телефоны и смартфоны
- Смартфоны
- Мобильные телефоны
- Рации, внутренняя связь
- Аксессуары для мобильных телефонов
- Реплики и муляжи телефонов
- Камеры
- Игола для снятим Sim кард
- Пульт Bluetooth для камеры
- Устройства громкой связи для мобильных телефонов
- Безпроводное зарядное устройство
- Зарядные устройства для мобильных телефонов
- Bluetooth гарнитура, наушники
- Держатели для телефонов
- Чехлы
- Кабель для передачи данных
- Внешние аккумуляторы Power bank
- Защитные пленки на экран
- Переходники и адаптеры
- Объективы для смартфонов
- Селфи-палки
- Проводные гарнитуры
- Адаптер Bluetooth
- Аккумуляторы для смартфонов
- Чехлы с принтом
- Радиатор, охлаждение мобильного телефона
- Светомузыка
- Широкий экран для телефона
- Держатель SIM-карты
- Попсокет
- Колльцо держатель
- Стабилизатор для мобильного телефона
- Аккумуляторы для смартфонов
- Синий Корпус гарнитуры
- Мобильный экран палуба/тот же скрининг
- Стилусы
- Другие аксессуары для мобильных телефонов
- Кнопки и клавиатуры для смартфонов
- Дисплеи для смартфонов
- Блокировщики сигналов телефонов
- Инфракрасный адаптер
- Аксессуары для работы с SIM-картами
- Резаки для SIM-карт
- Сетевое оборудование
- Сетевой шкаф
- Другое сетевое оборудование, аксессуары
- Волоконно-оптическое оборудование
- Беспроводные маршрутизаторы
- Оптоволокно
- Устройства VPN
- Беспроводные сетевые карты
- Конвертеры, коммутаторы
- Маршрутизаторы
- Усилители сигнала
- Сетевое хранилище
- Другие беспроводные сетевые устройства
- Повторители
- Брандмауэры
- Цифровая телефонная линия
- Сетевые карты
- VoIP-шлюз
- Оборудование для мониторинга беспроводной сети
- Видео сплиттеры
- Оборудование для переключения цифровой передачи
- Цифровые сетевые коммутаторы
- Волоконно-оптический приемники
- Сетевые концентраторы
- Сетевое тестовое оборудование
- Сетевой кард-ридер 3G / 4G
- Модемы
- Беспроводные точки доступа
- Витая пара
- Интегральные схемы
- Оборудование для прокладки сетей
- Карта физической изоляции
-
Ткань, кожа, пряжа, фурнитура текстильная
- Портьерная ткань
- Ткань из химического волокна
- Нейлоновая ткань
- Вискоза
- Другие ткани из химического волокна
- Полиэстер
- Лён и другие натуральные ткани
- Джутовая ткань
- Рами
- Ткань для штор и скатертей
- Льняная ткань
- Сизаль
- Другие льняные ткани
- Пряжа
- Шерстяная пряжа
- Другая пряжа
- Кашемировая пряжа
- Льняная пряжа
- Хлопковая пряжа
- Пряжа из химических волокон
- Шелковая пряжа
- Пряжа смесовая
- Необычная пряжа
- Трикотажная ткань
- Жаккард
- Трикотаж резинка
- Фланель
- Махровая ткань
- Трикотаж с начесом
- Другой трикотаж
- Сетка, тюль, фатин
- Кружевная ткань
- Джерси
- Неопрен
- Хлопчатобумажная ткань
- Бязь и тик
- Джинсовая ткань
- Хлопок саржа
- Поплин
- Вельвет
- Сатин
- Другая хлопковая ткань
- Костюмная хлопковая ткань
- Кожа
- Свиная кожа
- Овчина
- Кордовская кожа
- Кожа из ПВХ
- Искусственный мех
- Другая кожа
- Искусственная кожа
- Коровья кожа
- Сток текстиля
- Ткань шелкового плетения
- Натуральный шелк
- Креп
- Подкладочная шелковая ткань
- Жоржет
- Другая ткань шелкового плетения
- Сатин
- Парча
- Шифон
- Нетканые материалы
- Клеевая ткань, флизелин
- Спанбонд
- Другие нетканые материалы
- Спанлейс
- Фетр
- Дублерин
- Ткань Тик
- Синтетический Тик
- Хлопчатобумажный Тик
- Тик смесовый
- Льняной и джутовый Тик
- Другой Тик
- Химическое волокно
- Полиэстер в гранулах
- Полиэфирное волокно
- Нейлоновое волокно
- Акриловое волокно
- Спандекс волокно
- Полипропиленовое волокно
- Виниловое волокно
- Функциональное волокно
- Искусственное волокно
- Другое химическое волокно
- Смесовые ткани
- Смесовые ткани хлопок и полиэстер
- Смесовые синтетические ткани
- Другие смесовые ткани различного плетения
- Полульняные ткани
- Полушерстяные ткани
- Смесовые ткани жаккардового плетения
- Шерстяные ткани
- Шерстяная смесовая ткань
- Драп
- Шерстяная натуральная ткань и плюш
- Другие шерстяные ткани
- Швейная фурнитура
- Меховые шарики
- Меховые воротники
- Наполнитель для подушек и мягких игрушек
- Другие ленты и шнуры
- Подкладочная ткань
- Пуговицы
- Ленты
- Нитки швейные
- Шнуры и веревки
- Блестки, пайетки, стразы
- Липучки
- Кружево и окантовки
- Нитки для бирок
- Ярлыки для одежды
- Нашивки на одежду
- Другая швейная фурнитура
- Швейная фурнитура
- Кисточки и бахрома
- Мех на капюшон
- Молнии
- Наплечники
- Резинки
- Застежки для молний
- Стразы горячей фиксации
- Войлок и аксессуары для валяния
- Ткани с пайетками и набивным рисунком
- Функциональные ткани
- Жаккард
- Печать на ткани на заказ
- Натуральное текстильное сырье
- Льняное волокно
- Другое натуральное текстильное сырье
- Хлопковое сырье
- Хлопковое остаточное сырье
- Коконы шелкопряда, шелковое сырье
- Шерсть и щетина животных
- Меховые шкуры
- Перо, пух
- Прочий текстиль, кожа
-
Все для Кухни
- Кухонные принадлежности, инструменты
- Приспособления для колки орехов
- Антискользящие прищепки на посуду
- Шприцы-дозаторы, бутылочки для лекарств
- Другие кухонные инструменты
- Кухонные лопатки, ложки и другое
- Терки и ручные комбайны для нарезки
- Овощечистки
- Ситечки
- Формочки для льда
- Сумки-холодильники
- Открывалки и штопоры
- Формочки для пельменей и вареников
- Разделочные доски
- Чеснокодавилки
- Упаковка для кухни
- Таймеры для кухни
- Щипцы для еды
- Дуршлаги и миски для промывки
- Ручные соковыжималки
- Скалки
- Приправная посуда
- Емкость для льда
- Мороженое
- Ткань для пара
- Кухонный инструмент комплект
- Чистка Кокоса
- Сеточки для приправы
- Чистящее устройство
- Тендрайзер для мяса
- Измельчитель мяса
- Отбивной молоток
- Щипцы
- Форма для фрикаделек
- Раковинный фильтр
- Крышки для еды
- Коврик для замешивания
- Шприц для приправы
- Форма для жарки
- Защитная панель
- Аксессуары для кухонной утвари
- Резка яиц
- Нож для криветок
- Чистка семян
- Чистка апельсина
- Формочки для риса
- Венчик
- Суши набор
- Панель для готовки
- Масленница
- Дозатор
- Резак для пищевой пленки
- Дозатор для соуса
- Лопатки
- Контейнер для овощей
- Защита от брызг
- Инструменты разные
- Кухонный шприц
- Мешок для замешивания теста
- Поддержка для бутилированной воды
- Сушилки
- Водяной совок
- Насадка на кран
- Накладка на печь
- Инструмент для чистки креветок
- Щетка для посуды
- Пароварки и сетки для варки на пару
- Фрукторезки
- Держатели для зубочисток
- Измельчители
- Воронки с сеточками
- Пищевая пленка и пакеты для хранения
- Держатели для стаканов и бокалов
- Фольга и одноразовые изделия из фольги
- Другие аксессуары для кормления
- Гармония панель
- Микроволновая печь/стойка для духовки
- Все для выпечки и кондитерского дела
- Венчики
- Скребки
- Формочки для шоколада
- Формочки для выпекания
- Бумага и листы для выпекания
- Другие кондитерские инструменты
- Кондитерские трубочки
- Комплекты для выпечки
- Большие формы для выпечки
- Формочки для пироженых
- Противень формочка
- Лунный пирог
- Вафельница
- Колбаса
- Посуда из нержавейки
- Подставка под выпечку
- Разные формы
- Мерные ложки и стаканы
- Ситечки и ручные просеиватели
- Лопатки и кисточки
- Отделитель желтка от белка
- Шпатель для теста
- разное для выпечки
- Коврик для запекания
- Чаша для запекания
- Бисквитная форма
- Торт верх Спрайт
- Снежинка хрустящая
- Цветочный рот конвертер
- Посуда для отелей и кафе
- Одноразовые палочки для еды
- Одноразовый нож, вилка, ложка
- Западная посуда комплект
- Стекло комплект
- Предметы в упаковке
- Другая посуда для отелей
- Корзинки для фруктов
- Пиалы и глубокие тарелки
- Посуда для кормления
- Тарелка
- Ложки для супа
- Наборы столовых приборов
- Ложки, вилки, ножи, палочки
- Салфетки на стол и подставки под горячее
- Ланчбоксы, контейнеры для еды
- Наборы тарелок
- Блюдо
- Керамическая посуда комплект
- Одноразовые перчатки
- Силиконовые крышки на тарелки и посуду
- Другие наборы посуды
- Вилки для фруктов
- Одноразовый ланч -бокс
- Палочки для еды
- Керамическая посуда
- Пластиковые предметы
- Рисовый бочонок
- Коврик для еды
- Разная посуда
- Ложки
- Блюдо для еды
- Термос
- Для отеля
- Одноразовая посуда
- Одноразовые контейнеры для еды
- Бумага удалитель жира
- Экологически чистая посуда
- Комплект одноразовой посуды
- Контейнеры для еды
- Димсам
- Палочки для еды
- Рамки для еды
- Тазики для еды
- Украшения для стола
- Одноразовые скатерти
- Палочек для еды
- Кастрюли, сковороды и чайники
- Толстостенные керамические горшки
- Крышки для кастрюль и сковород
- Наборы кастрюль и сковород
- Сковороды
- Сковороды-вок wok
- Скороварки
- Кастрюли
- Мини-сковороды для омлетов и яичниц
- Другие кастрюли и сковороды
- Кастрюли для молока
- Двойные и другие сковороды
- Пароварки
- Керамические кастрюли
- Походная посуда
- Термосы для еды
- Посуда в духовой шкаф
- Газовая печь
- Эмалированная посуда
- Ручки, крышки
- Многофункциональные электросковороды
- Кастрюли на спиртовой горелке
- Традиционная китайская посуда
- Чашки и кружки
- Одноразовые бумажные стаканчики
- Чайники из нержавеющей стали
- Складные пластиковые емкости под воду
- Одноразовые подставки под стаканы
- Бутылки и стаканы из стекла
- Кружки и бутылки из пластика
- Керамические чашки
- Мини-термосы
- Другие чашки и кружки
- Графины для холодных напитков
- Mark Cup
- Прорезыватели игрушки для режущих зубов
- Бутылочки для кормления
- Соски на бутылочки
- Кружки непроливайки
- Крышки на бутылочки
- Чашка пластиковая
- Трубочки для напитков
- Спортивные бутылки
- Одноразовые пластиковые чашки
- Бутылка -связанная
- Чайники-термосы
- Чехол для кружки
- Air up бутылочки
- Подставка "Круг" под стакан
- Чашка с соломкой
- Туристический термос
- Водяная посуда комплект
- Генератор водородной воды
- Чашка соковыжималка
- Чашка с двойным дном
- Лимонная чашка/Сюэке чашка
- Чашка для молока
- Чашка комплект / для влюбленной пары
- с крышкой
- Чашка
- Спрей, бутылка для воды
- Шейкер
- Чашка Ополаскиватель
- Умная водяная чашка
- Большие термосы и термопоты
- Все для Кофе
- Кружки для кофе
- Кофейники
- Кофейные сервизы
- Ручные кофемолки
- Устройство шлифования кофе, порошок пресс
- Разные приборы для кофе
- Ёмкости для кофе
- Сахарный цилиндр
- Молочник из нержавейки
- Разные насадки, фильтра
- Кофейная ложка
- Кофейная фильтровая бумага
- Французский кофейник
- Восточный кофейник
- Гейзерная кофеварка
- Принадлежности для барбекю
- Кисти и щетки
- Мультитул
- Жаровни, мангал
- Лопатки, щипцы и другие инструменты для готовки
- Решетки для жарки
- Другие принадлежности для барбекю
- Вилки и шампуры и палочки
- Уголь для жарки
- Сковороды и подносы
- Бамбуковые палочки
- Сухое горючее
- Коптильня
- Костровище
- Защитный экран для барбекю
- Барбекю
- Насадка на балон
- Кухонные ножи и ножницы
- Держатели кухонных инструментов
- Наборы ножей
- Ножи из нержавеющей стали
- Фруктовый нож
- Кухонные ножницы
- Точильные камни
- Керамические ножи
- Другие ножницы
- Нож для пиццы
- Нож - топор
- Костный резак
- Нод для мясса
- Сашими
- Нож для хлеба
- Сырный нож
- Западный нож
- Шеф -повар
- Нож ручной работы
- Разные наборы
- Кулинарный нож
- Для стейка
- Кишечный нож
- Сейттер
- Все для вина
- Винные стойки
- Щипцы и ведерки для льда
- Винные бокалы
- Винные наборы
- Винные пробки
- Коктейльные шейкеры
- Фляжки
- Декантеры
- Грелка, для Сакэ
- Кубики льда из нержавеющей стали
- Сплиттер, мерный стакан
- Палочки в бакал
- Ледяные кубики
- Фильтр
- Винный черпак
- Вина
- Ледяной фильтр
- Бочки для вина
- Другие аксессуары для вина
- Кипяченое вино
- Товары для чайной церемонии
- Дорожные наборы для чайной церемонии
- Чайники для чайной церемонии
- Аксессуары для чайной церемонии
- Баночки для чая
- Чайные доски чабани
- Чашка
- Пиалы для чайной церемонии
- Другие принадлежности для чайной церемонии
- Одноразовый набор для чая
- Уголь для чая
- Чайные фигурки
- Заварочный чайник
- Чашка с носиком
- Френч пресс
- Чайная чашка
- Чайный фильтр
- Чайный пинцет
- Блюдца
- Travel Tea Set
- Комплект Кунг -фу чай
- Цветочный чайный набор
- Чайная ложка
- Пиалка
- Приготовление на древесном угле
- Фигурки
- Горелка для благовоний
- Подставка под чайник
- Заварник
- Крышечки
- Чайный набор
- Подарочный набор
- Чайные коврики/чайные прокладки
- Чайное ведро
-
Средства ежедневной гигиены и уборки дома
- Средства для стирки и чистки одежды
- Пластинки для цветных тканей
- Освежитель обуви
- Кондиционер для белья
- Средства для стирки детских вещей
- Жидкий крахмал
- Отбеливатели
- Ручка для удаления пятен
- Кондиционер для нижнего белья
- Хозяйственное мыло
- Таблетки для стирки
- Прочие средства для чистки одежды
- Пятновыводители
- Жидкость для стирки
- Стиральный порошок
- Ароматизатор для стирки
- Отбеливатель
- Бумажная и гигиеническая продукция
- Туалетная бумага в диспенсеры
- Рулон бумаги
- Тканевые салфетки
- Бумажные полотенца в диспенсеры
- Бумажные салфетки
- Туалетная бумага и одноразовые сидения
- Влажные салфетки
- Бумажные полотенца в рулонах
- Кухонные бумажные полотенца
- Другая бумажная и гигиеническая продукция
- Ультратонкие подгузники
- Впитывающие трусики, подгузники
- Влажные салфетки для младенца
- Детские бумажные салфетки и полотенца
- Влажные салфетки
- Влажные салфетки
- Классические подгузники
- Влажные салфетки
- Бумажные салфетки
- Бумажные салфетки в промо-упаковке
- Дезодоранты и ароматизаторы
- Угольные поглотители запаха
- Средства для удаления химических запахов
- Освежитель в холодильник
- Ароматные палочки
- Восковые пахучки
- Ароматерапия
- Нафталиновые шарики
- Другие ароматизаторы и очистители воздуха
- Ароматизаторы для помещений
- Освежители воздуха для туалетов
- Дезодоранты для обуви и холодильников
- Ароматические саше для шкафов
- Ладан, ароматный аромат
- Чистящие средства для кухни
- Средства от накипи
- Средства для мытья посуды
- Средства для чистки кафеля
- Стеклоочистители
- Для посудомоечной машины
- Чистота в доме
- Для унитаза
- Универсальные моющие средства
- Средства для туалетов
- Средства для чистки стиральной машины
- Средства для очистки от жира
- Средства для чистки труб
- Средства для чистки бутылочек, фруктов и овощей
- Другие чистящие средства для кухни
- Уход за полостью рта
- Средства для чистки протезов
- Отбеливатель для зубов, наклейка
- Оральный спрей
- Чистка языка
- Зубная щетка/ комплект
- Зубные щетки для младенцев
- Зубные щетки
- Зубочистки и зубные нити
- Другие средства по уходу за полостью рта
- Зубные пасты
- Комплекты по отбеливанию зубов
- Зубные щетки и пасты для младенцев
- Карандаши для отбеливания зубов
- Полоскание для рта
- Освежители полости рта
- Зубные порошки
- Парики и уход за париками
- Парики с короткими прямыми волосами
- Шиньон челка
- Уход за париком
- Мужские парики
- Парики с длинными вьющимися волосами
- Другие виды париков
- Парики для косплея
- Парики с длинными прямыми волосами
- Шиньон конский хвост
- Парики с короткими вьющимися волосами
- Шиньоны, накладки и пряди
- Парики из натуральных волос
- Средства для ухода за телом
- Воск, крем для депиляции
- Пена для бритья
- Пластырь для похудения
- Макияжа
- Уход за ногами
- Крем
- Отшелушивание ступни
- Детские Увлажняющее молоко
- Детский крем
- От выпадение волос
- Уход за руками
- Кремы и лосьоны для тела
- Другие средства для ухода за телом
- Кремы для похудения
- Тело отшелушивание
- Средства для ухода за шеей
- Foot Film
- Пенка для рук
- Средства для ухода за грудью
- Женская забота
- Средства гигиены для беременных
- Подгузники для взрослых
- Прокладки
- Другие товары для молодых мам
- Интимная гигиена
- Частный аромат
- Комплекты необходимых вещей в роддом
- Прокладки после родов
- Тампоны и менструальные чаши
- Прокладки
- Уход за другими женщинами
- Прокладки и гигиенические средства
- Средства для интимной гигиены
- Одноразовые пеленки
- Средства для ухода за полом
- Моющие средства для пола
- Средство для чистки ковров
- Средства для чистки ковров
- Воск для пола
- Другие средства для ухода за полом
- Средства для уборки
- Средства для удаления плесени
- Средства по уходу за кожаной мебелью
- Средства для чистки текстильных поверхностей
- Крем для обуви
- Очистители для кондиционеров
- Очистка прибора
- Другие средства для уборки дома
- От комаров
- Детские репелленты
- Цветочная вода и спреи от насекомых
- Охлаждение масла
- Репеллентный браслет комаров
- Катушки комаров/ломтики катушки комаров
- Средства от насекомых
- Антиподы
- Какп
- Ролик
- Демоскопия анти -москито -эксплуатационное агент
- Персональная обработка династии Цин
- Обработка дезинфекционных бактериостатических поставки
- Обработка личной гигиены
- Обработка ухода за женщинами
- Ежедневная обработка потребностей
- Обработка Life Paper
- Обработка парика
- Уход за волосами
- Шампуни
- Краска для волос
- Аксессуары для окрашивания волос
- Маски для волос
- Масла для ухода за волосами
- Комплекты по уходу за волосами
- Другие средства для ухода за волосами
- Гели, воски и термозащитные средства
- Увлажняющие маски и кондиционеры
- Тени для волос, спрей
- Уход за кожей головы
- Средства против выпадения волос
- Кондиционеры
- Биоламинирование волос
- Мужская процедура
- Мужской Продукт по уходу за волосами
- Процедура
- Мужской Антипитроферирование
- Мужской Очистка тела
- Мужской Сексуальная частная часть
- Мужской Прачечная
- Мужской шампунь
- Дезинфекция бактериостатических принадлежностей
- Дезинфицирующие средства
- Мытье бактериального геля
- Домашняя дезинфекция
- Дезинфекция
- Berbal Laundry Liquid, Prought Powder
- Бактериальное мыло, порошок
- Бактериостатическое мытье рук
- Дезинфекция бактериостатических принадлежностей комплект
- Средства для ухода за телом
- Средства для мытья младенцев
- Отбеливающие средства
- Комплекты для принятия ванны
- Присыпки
- Инструменты по уходу за телом
- Детские Подарочная коробка для купания кожи
- Детские Порошок для тела Shuang/порошок головастика
- Антипитроферирование
- Уход за ногами
- Комплекты по уходу за телом
- Лосьон для тела, гель для душа
- Другие товары для гигиены младенцев
- Мыло ручной работы
- Пемзы и терки для стоп
- Антиперспиранты
- Соль для ванн
- Ванночки для ног
- Арома средства для ванны
- Мыло для рук
-
Все виды освещения
- Наружное освещение
- Прожекторы для тоннелей
- На открытом воздухе ночь свет
- Прожекторы для освещения площадей и стоянок
- Индукционные лампы
- Освещение для мостов и причалов
- Другое уличное освещение
- Освещение для пола, дорожек и ступенек
- Светящаяся плитка для тротуаров и дорожек
- Светодиодные трубки для иллюминации
- Уличное освещение
- Водонепроницаемые трубки для освещение стен
- Светодиодные водонепроницаемые ленты
- Светодиодные светильники дуговые
- Светодиодные панели с цифрами
- Газонные светодиодные светильники
- Подводная подсветка и освещение
- Тротуарные светильники
- Светодиодные уличные фонари
- Ландшафтные прожекторы
- Освещение на солнечных батареях
- Декоративные уличные фонари
- Ручные прожекторы
- Водонепроницаемые уличные прожекторы
- Точечное уличное освещение
- Светодиодные трубки
- Настенные светильники
- Иллюминация
- Водонепроницаемые прожекторы
- Лампы накаливания
- Инфракрасная лампочка
- Цветные лампочки
- Лампочки для фотокамер
- Миниатюрные лампочки
- Прожекторные лампы
- Подводные лампы
- Бестеневые лампы для медицинских кабинетов
- Другие лампы накаливания
- Обычные лампы накаливания
- Вольфрамовые галогенные лампы
- Индикаторная лампочка
- гирлянды led
- Светодиодные гирлянды
- Декоративное освещение
- Светодиодные экраны
- Другие экраны
- Светодиодный навесной экран
- Переносные светодиодные экраны
- Блоки питания для экранов и дисплеев
- Плата управления светодиодным экраном
- Программное обеспечение для экранов
- Светодиодные матрицы
- Другие светодиодные экраны и запчасти к ним
- Светодиодные информационные дисплеи
- Светодиодный экран для помещений
- Светодиодные наружные рекламные экраны
- Лампы разные
- Другие компоненты для ламп
- Колбы для ламп
- Нити для ламп накаливания
- Фосфор для ламп
- Ножки лампы с электродами
- Светодиодное управление
- Диммирование, цвет
- Светодиодные драйвера IC
- Светодиодные контроллеры освещения
- Светодиодные системы управления
- Другие светодиодные приводы и управление
- Блоки питания
- Светодиодная подсветка
- Другие светодиодные фонари
- Модуль подсветки малого размера
- Модуль подсветки среднего размера
- Модуль подсветки большого размера
- OLED освещение
- OLED-освещение
- OLED-дисплей
- OLED-драйвер
- OLED-материал
- OLED-устройство
- Другие OLED
- Светодиодные устройства
- Цветные светодиодные лампы RGB
- Другие светодиодные лампы
- Пластиковые чехлы
- Светодиодные лампы SMD
- Светодиоды выводные
- Светодиодные лампы высокой мощности
- Светодиоды на COB
- Светодиодное производственное и испытательное оборудование
- Светодиодное старение
- MOCVD
- Светодиодное устройство
- Световое упаковочное оборудование
- Оборудование для производства светодиодных ламп
- Светодиодная эпитаксиальная инспекционная аппаратура
- Оборудование для тестирования светодиодных чипов
- Оборудование для тестирования светодиодных приборов
- Светодиодное осветительное оборудование
- Другое светодиодное производственное и испытательное оборудование
- Холодные источники света
- Другие холодные источники света
- Электролюминесцентные провода
- LED поддерживающий Служить
- Служба сертификации светодиодов
- Служба тестирования светодиодов
- Освещение дизайн
- Осветительная техника стандартный
- Отчет о исследованиях
- Другие светодиоды поддерживающий Служить
- Сотрудничество проекта осветительного оборудования
- Светодиодные сменные лампочки
- Составить зеркало свет Пузырь
- Стерилизатор кукуруза свет
- Светодиодные лампочки для гирлянд и декора
- Светодиодные лампочки для прожекторов
- Светодиодные люминесцентные лампочки
- Светодиодные лампочки типа «кукуруза»
- Светодиодная лампочка со штырьковым цоколем
- Светодиодные классические лампочки
- Другие светодиодные лампочки
- Горизонтальные светодиодные лампочки
- Лампочки для светодиодных свечей
- Стерилизовать свет Трубка
- Световые индикаторы
- Лампочки и детали для световых индикаторов
- Освещение аварийных барьеров и ограждений
- Аварийные световые индикаторы
- Сигнальный свет
- Другие световые индикаторы
- Энергосберегающие и ксеноновые лампы
- Ксеноновые лампы
- Другие лампы
- Лампы с неоновым светом
- Люминесцентные лампы
- Энергосберегающие лампы
- Лампы дневного света
- Неоновые трубки и лампы
- Натриевые газоразрядные лампы
- Ртутные газоразрядные лампы
- Галогенные лампы
- Ультрафиолетовые лампы
- Аксессуары для осветительных приборов
- Светодиодные подсветки
- Светодиодные отражатели
- Светодиодные платы
- Контроллеры ламп
- Светодиодные разъемы
- Триггеры
- Оптические блоки
- Держатели и крепления для ламп
- Корпус для ламп дневного света
- Столбы для уличных фонарей
- Стартеры
- Электронный балласт
- Светодиодные излучатели
- Светодиодные лампы
- Другие аксессуары для светодиодного освещения
- Другие запчасти и аксессуары для ламп
- Патроны и держатели ламп
- Корпуса для прожекторов и ламп
- Плафоны, рефлекторы и кожухи для светильников
- Рефлекторы
- Сырье для производства светодиодных ламп
- Светодиодные эпитаксиальные пластины
- Светодиодные кронштейны
- Источники MO
- Керамические подложки
- Золотая нить
- Люминафор
- Клей
- Клей за заполнения
- Стекла для фонарей
- Светодиодные линейки и панели
- Другие материалы для изготовления ламп
- Светодиодные красные чипы
- Светодиодные осветительные модули
- Светодиодные модули потолочного освещения
- Светодиодные лампы
- Светодиодные модули люминесцентных ламп
- Светодиодные светильники
- Светодиодные прожекторы
- Модули светодиодных панелей
- Светодиодные уличные фонари
- Светодиодные модули для освещения тоннелей
- Другие светодиодные осветительные модули
- Без хозяин свет освещение
- Светодиодные прожекторы
- Встраиваемые светильники с несколькими лампами
- Магнитный свет
- Потолочные, точечные люминесцентные светильники
- Светодиодные ленты
- Прожекторы
- Светодиодные лампы
- Цилиндрические светильники
- Люстры
- Светодиодные кухонные светильники
- Декоративное освещение
- Люстры потолочные
- Настенные светильники
- Потолочные светильники
- Набор свет Инструмент
- Другое освещение
- Люстры потолочные с вентилятором
- Торшеры
- Галогенные, кварцевые лампы
- Люминесцентные лампы
- Лампы для зеркал
- Фонарики и портативное освещение
- Другие фонарики
- Фонарики на велосипед
- Ручные фонарики
- Налобный фонарик
- Фонарики дубинки для самозащиты
- Ручной прожектор
- Рыболовные светильники
- Фонарики на подставке
- Аксессуары для фонариков
- Наручные часы с фонариком
- Взрывозащищенные фонарики
- Переносные светодиодные лампы
- Фонарики
- Коммерческое освещение
- Светодиодная панель
- Линейные светодиодные светильники
- Подвесные светодиодные светильники
- Потолочное освещение
- Парикмахерские лампы
- Встраиваемые светильники в шкафы
- Лампы для подсветки подоконника и оконных рам
- Лампы аварийного освещения
- Другая светотехника
- Необычные ночники
- Креативные ночники
- Ночник с зарядной станцией
- Смарт-ночники
- Ночники
- Настольные лампы для чтения
- Декоративные настольные лампы
- USB-светильники
- Настольные лампы
- Креативные настольные лампы
- Светильник с зарядной станцией
- Атмосфера с проекцией свет
- Смарт-светильники
- Защита глаз экрана свет
- Прохладный свет
- Подобрать свет
- Освещение специального назначения
- Индукционные лампы
- Освещение для спортивного зала
- Инфракрасные лампы и аксессуары
- Промышленные и горные светильники
- Взрывозащищенные светильники
- Другие лампы специального назначения
- Освещение для фруктово-овощных прилавков
- Передвижное освещение для сцены
- Освещение вращающиеся головы
- Лазеры
- Мягкий свет
- Бестеневые светодиодные лампы
- Светодиодные лампы-приманки рыбалки
- Освещение для АЗС и АГЗС
- Исследовательские лампы
- Ультрафиолетовые лампы для стерилизации
- Висящая стерилизация свет
- Руковолочная стерилизация свет
- Туалет свет
- Декоративное освещение
- Освещение для фотостудий
- Освещение для медицинских кабинетов
- Освещение сцены
- Светодиодные лампы для выращивания растений
- Подсветка для наружной рекламы
- Чипы и эпитаксиальные материалы для светодиодов
- Светодиодные инфракрасные чипы
- Светодиодные синие чипы
- Светодиодные оранжевые чипы
- Светодиодные желтые чипы
- Светодиодные желто-зеленые чипы
- Светодиодные зеленые чипы
- Светодиодные фиолетовые чипы
- Светодиодные ультрафиолетовые чипы
- Другие светодиодные чипы
- Осветительное оборудование
- Светодиодные обозначения и указатели
- Сигнальные огни для светофоров и указателей
- Световые индикаторы
- Светодиодные вывески
- Светодиодные панели для рекламы
- Светодиодные вывески для торговых заведений
- Другая светодиодная реклама
- Светодиодные логотипы
- Другое рекламное освещение
- Светодиодные рекламные баннеры
- Светодиодные надписи и логотипы
- Другие светодиоды
- Светодиодные контроллеры
- Лампы и прожекторы на консигнационном складе
- Другие светодиодные изделия
-
Товары для взрослых
- Товары для мужчин
- Массажеры простаты
- Насадка на пенис
- Силиконовые куклы
- Спрей для продления полового акта
- Виброкольцо
- Мастурбаторы
- Мастурбатор-яйцо EGG
- Надувные куклы
- Искусственные вагины
- Другие товары для мужчин
- Товары для женщин
- Анальные стимуляторы
- Зажим для сосков
- Устройства для сосков
- Вибраторы
- Фаллоимитаторы
- Разные эротические товары
- Виброяйцо
- Тренажеры для вагинальных мышц
- Другие товары для женщин
-
Защитное снаряжение, оборудование и системы безопасности
- Противоугонные сигнализации
- Защитные магнитные этикетки
- Телефонные сигнализации
- Интегрированная охранная система
- Сейфы
- Тревожные кнопки
- Другие сигналы тревоги и устройства сигнализации
- Другое противоугонное оборудование и сигнализации
- Защита рук
- Анти -заканчивая перчатки
- Сварщик перчатки
- Антистатический перчатки
- Долговечный высокая температура перчатки
- Изоляция перчатки
- Универсальный перчатки
- Предотвращать перчатки
- Одноразовые перчатки
- Низкая температура перчатки
- Другая защита рук
- Медицинский перчатки
- Знаки и наклейки пожарной безопасности
- Производственные знаки безопасности
- Другие знаки пожарной безопасности
- Указатели пожарных выходов
- Знаки дорожного движения
- Защита глаз
- Анти -импульс зеркало
- Антихимический глаз зеркало
- Анти туман зеркало
- Очки, УФ-защита
- Пыль -защищенная зеркало
- Защитный глаз накладка
- Другая защита глаз
- Комплексный защитный глаз зеркало
- Медицинский зеркало
- Светло -надежный радиационный глаз зеркало
- Оборудование для мониторинга безопасности
- Энкодеры
- Удаленный мониторинг автомобилей, телефонов
- Крепления и кронштейны для камер
- Защитные кожухи и корпуса для камер
- Мониторы
- Поворотные купольные камеры
- Мониторные панели
- Интегрированный мониторинг
- Коммутаторы
- Камеры наблюдения
- Другие аксессуары для установки камер наблюдения
- Крепления и кронштейны для мониторов
- Другое оборудование для мониторинга
- Домофоны
- Другие домофоны
- Невизуальные домофоны
- Беспроводные дверные звонки
- Визуальные домофоны
- Взрыв -защищенное оборудование
- Взрывное одеяло
- Взрыв -надежный бак
- Взрыв -надежный шлем
- Взрывной шкаф
- Взрывобезопасный
- Взрывобезопасный
- Взрыв -надежная стальная вилка
- Взрывной щит
- Анти -клуб
- Взрывная палка
- Взрывобезопасный дверь
- Взрывозащитное оборудование и снаряжение
- Антистатический продукт
- Антистатический инструмент
- Промышленный влажный шарф
- Вытирать
- Электроэнергетика, генератор
- Антистатическая занавеска
- Анти -статическая кисть
- Антистатический перчатки Браслет
- Анти -статическая форма и аксессуары
- Без Пыльная бумага, без Пыльная ткань
- Антистатический пакет Материал
- Антистатический панель
- Антистатическое кресло
- Ион
- Ионная змея
- Ион
- Другие антистатические продукты
- Антистатическая площадка
- Интеллектуальное оборудование для парковок
- Оборудование для контроля въезда
- Другое интеллектуальное дорожное оборудование
- Глаза
- Оборудование для безопасности дорожного движения
- Одежда для безопасности движения
- Дорожные ограждения
- Сигнальные столбики
- Лежачие полицейские
- Туннель
- Звуковой барьер
- Дорожные конусы
- Сигнальные подсветки дорожной разметки
- Сферические зеркала
- Птица -диспетчер
- Пирс
- Индукция в форме линии стандартный
- Выход стандартный столбец
- Предупреждаемая куча
- Дорожные отражающие стеклянные микроэлементы
- Водяной лошадь
- Антибликовый панель
- Управляемые столкновения
- Ящик для расследования дорожно -транспортного происшествия
- Подъемная дорожная куча
- Трафик командования
- Устройство индукционного индукционного индукционного устройства с туманной областью
- Туннельный контурный ремень
- Другое оборудование для безопасности дорожного движения
- Светоотражающие ленты и материалы
- Промышленное увлажнитель
- Инвентарь, вторые продукты безопасности
- Продукт безопасности инвентаря
- Тревога
- Другая тревога
- Детектор тревоги
- Аварийный аксессуар
- Хост тревоги
- Передающее оборудование
- Другое передающее оборудование
- Оптические трансиверы
- Системы беспроводной передачи данных
- Другой мир полностью Защитная экипировка
- Системы контроля и управления доступом
- Замки с пин-кодом
- Дверные доводчики
- Контроллеры доступа
- Система управления картами
- Системы контроля доступа
- Другое оборудование и системы контроля доступа
- Электронная система патрулирования
- Устройство считывания карт контроля доступа
- Оборудование для управления дорожным движением
- Сигнальные дорожные огни
- Светящиеся жезлы регулировщика
- Дорожные контроллеры
- Дорожные светофоры и контроллеры
- Другое оборудование управления движением
- Мягкая лестница, лестница Escape
- Охранное оборудование
- Противоугонное оборудование
- Арочные металлодетекторы
- Считыватели ID-карт
- Другое охранное оборудование
- Ручные металлодетекторы
- Защита лица
- Защитный поверхностный экран
- Защитная поверхность накладка
- Другая защита лица
- Системы умный дом
- Другие системы умный дом
- Интеллектуальный дверной замок
- Системы умный дом
- Детектор газа
- Детектор угарного газа
- Детектор алкоголя
- Другие газо анализаторы
- Детектор горючий газ
- Кислородный детектор
- Сульфидный детектор
- Детектор диоксида азота
- Детектор оксида азота
- Детектор диоксида серы
- Детектор хлора
- Детектор водорода
- Детектор хлорида водорода
- Детектор углекислого газа
- Системы записи и мониторинга
- Другое записывающее оборудование
- Сетевые видеорегистраторы DVR
- Акустические датчики и звукосниматели
- Звуковые карты
- PCI карты
- Другая защита домашних заданий
- Промышленная и коммерческая уборка
- Оборудование для очистки питьевой воды
- Оборудование для очистки и чистки с наложениями
- Фильтр хлопок
- Другое оборудование для чистки и чистки
- Скраб
- Коммерческая посудомоечная машина
- Промышленный вакуум
- Добавить машину для благовоний, чистящая машина
- Машина для уборки взрывов
- Прокладка
- Широкая машина
- Санитарный мусорное мусорное ведро
- Паровая чистящая машина
- Высокая Машина для очистки потока воды
- Ультразвуковое чистящее оборудование
- Промышленное очиститель воздуха
- Физическая защита
- Трудовая служба
- Анти -сервис
- Антистатическая форма
- Пожаротушение
- Медицинская защита
- Сварная одежда
- Пыль -защищенная
- Изоляция
- Другая защита тела
- Смарт-карты
- Другие смарт-карты
- Магнитные карты
- Штрих-код карты
- Бесконтактные RF-карты
- IC карты
- Информационная безопасность полностью продукт
- Другая информационная безопасность полностью продукт
- Защита головы
- Стеклянное подкрепление полностью кепка
- Хлопок установить полностью кепка
- Пластик полностью кепка
- АБС полностью кепка
- Шапка, из нетканого материала
- Другая защита головы
- Защита для дыхания
- Рот накладка Дыхательный клапан
- Медицинский рот накладка
- Рот накладка Прокладка
- Рот накладка переносица полосатый
- Другая защита дыхания
- Одноразовая медицинская маска
- Анти -сущность накладка
- Антивирусная маска
- Защита слуха
- Наушники, с ушками
- Другая защита слуха
- Беруши
- Защита ног
- Антихимическая обувь
- Защитные ботинки
- Пыль -защищенная
- Антистатическая обувь
- Анти -смаширование и анти -переживающая обувь
- Изоляционная обувь
- Другая защита ног
- Жизненное оборудование
- Спасательный жилет
- Спасательная шлюпка
- Круг для плавания
- Спасение жизни стандартный
- Жизненная веревка
- Спасение подставки
- Оборудование с другой жизнью
- Установить полностью сеть
- Другой мир полностью сеть
- Установить полностью Плоская сеть
- Восхождение сеть
- Корпус Почвенная сеть
- Затенение сети
- Антипатентная сеть
- Архитектурная безопасность полностью сеть
- Антиграсная сеть
- Хорошо корпус сеть
- Закрытие автомобиля
- Антитефта
- Анти -москитовая сеть
- Анти -птичная сеть
- Размножающаяся сеть
- Теплица
- Ветрозащитная, пыльная сеть
- Восхождение сеть
- Виноградные лозы
- Падать
- Окинава
- Установить полностью приносить
- Установить полностью веревка
- Имеет Ограниченное пространственное антиоборотное устройство
- Антипроцестанный разъем
- Скорость измерителя
- Якорное устройство
- Спасение штатива
- Life Line Device
- Оборудование для спасения/медленного сокращения
- Антипатент система
- Другая падающая защита
- Промышленное увлажнитель
- Ультразвуковой увлажнитель
- Испарить увлажнитель
- Электрический увлажнитель
- Увлажнитель
- Составной увлажнитель
- Комбинированная машина функции влажности
- Высокая Нажатие на небольшую моза тумана система
- Высокая Куча
- Другие увлажнители
- Увлажнительные аксессуары
- Защита от стихийных бедствий
- Впитывающие румяна
- Блокировка воды панель
- Геоморфный контроль наводнения
- Flood -control Geo -Film Film
- Благоприятный мешок с песком
- Подушка фильтра наводнения
- Профилактика наводнения вязанные сумка
- Профилактика наводнения свинцовый шелк
- Остановить мышь панель
- Жизненный зонд
- Другая защита от стихийных бедствий
- Защита безопасности
- Промышленная и коммерческая уборка
- Прокладка
- Оборудование для очистки и чистки с наложениями
- Другое оборудование для чистки и чистки
- Коммерческая посудомоечная машина
- Широкая машина
- Широкая машина
- Скраб
- Паровая чистящая машина
- Машина для уборки взрывов
- Добавить машину для благовоний, чистящая машина
- Высокая Оборудование для очистки выстрелов
- Ультразвуковое чистящее оборудование
- Промышленный вакуум
- Промышленное очиститель воздуха
- Фильтр хлопок
- Оборудование для очистки питьевой воды
- Промышленная чистящая робот
- Санитарный мусорное мусорное ведро
- Junk Accessessy
- Большая мусорная банка
- Медицинские отходы
- Дезинфекция опрыскивателя
- Адсорбированный
- Сигаретный столб
- Коммерческая наземная площадка
- Снегоочиститель
- Стиральная машина ковров
- Метла на открытом воздухе
- Земля
- Коммерческая дезинфекция
- Коммерческая стиральная машина
- Биометрическое оборудование
- Другое оборудование для идентификации
- Считыватели отпечатков пальцев
- Устройства распознавания лиц
- Оборудование Судмедэкспертизы
- Другое биометрическое оборудование
- В помещении полностью Тест
- Дезинфицирующее средство
- Инструмент обнаружения ЛОС
- Инструмент для обнаружения радио
- Формальдегидский инструмент обнаружения
- Инструмент обнаружения бензола
- Детектор аммиака
- Другие инструменты испытаний на защиту окружающей среды в помещении
- Защита для дыхания
- Материал фильтра для защиты дыхания
- Одноразовая медицинская маска
- Медицинский рот накладка
- Анти -сущность накладка
- Еда накладка
- Электрический новый Туйер накладка
- Антивирусная маска
- Самоавтороз дыхания воздуха
- Электрический в подарок Защита от фильтрации ветра дыхания система
- Избежать респиратора
- Длинная трубка газовая подача респиратор
- Рот накладка Прокладка
- Рот накладка переносица полосатый
- Рот накладка Дыхательный клапан
- Другие аксессуары для защиты дыхания
- Другая защита дыхания
- Защита ног
- Анти -смаширование и анти -переживающая обувь
- Нескользящая обувь
- Антистатическая обувь
- Изоляционная обувь
- Водонепроницаемый обувь
- Освободить обувь
- Холодная защита
- Защитные ботинки
- Антихимическая обувь
- Пыль -защищенная
- Долговечный высокая Теплые туфли
- Кислотный -лкали
- Масло -защитное
- Изоляционная обувь
- Другая защита ног
- Пламя замедляющего
- Вырезать носки
- Установить полностью стандартный знание
- Производство полностью стандартный знание
- A слово Карта
- Пожарная безопасность полностью стандартный знание
- Транспорт полностью стандартный знание
- Электричество система стандартный знание
- Земля стандартный знание
- Похороненный стандартный знание
- Отражение тела стандартный знание
- IMO Ship Использование стандартный знание
- Реклама стандартный знание
- Классификация мусора стандартный знание
- OSHA стандартный знание
- Верх Замок
- Предупреждающая линия
- Другой мир полностью стандартный знание
- Физическая защита
- Униформа страхования труда
- Операция питания щита
- Пыль -защищенная
- Сварная одежда
- Радиационный костюм
- Холодный
- Защитный костюм
- Медицинская защита
- Анти -сервис
- Антистатическая форма
- Высокая Визуальное предупреждение
- Изоляционное сопротивление высокая Теплая одежда
- Жилет
- Полив
- Изоляция
- Работник
- Низ Водяные штаны
- Пожаротушение
- Работайте плащ
- Умная одежда
- Мрачный
- Другая защита тела
- Оборудование для мониторинга безопасности
- Мониторинг кронштейна
- Мониторинг хоста
- Энкодер
- Фиксированная сетевая камера
- Сетевая камера шарика
- Сетевая камера Yuntai
- Симуляционная сеть камера
- Горячие продукты
- Видеть частота хранилище
- Хранилище данных
- Монитор
- Многоэкранный
- Информационный выпуск
- Электронная карта
- Управлять клавиатурой
- Процессор экрана
- Матрица
- Сервер сшивания
- Защищать накладка ,мяч накладка
- Другие периферийные аксессуары
- Интегрированный мониторинг система
- Другое мониторинг оборудования и система
- Декодер
- Оборудование для обнаружения движения
- Детекторы транспортных средств
- Весовой контроль
- Измерители освещения
- Другое оборудование обнаружения движения
- Противопожарное оборудование
- Противопожарное оборудование
- Оборудование для пожаротушения
- Умная пожаротушение
- Огнетушитель
- Пожарный гидрант
- Детекторы дыма
- Дымовые и газовые сигнализации
- Оборудование для уборки и сушки огня
- Пожарный случай
- Огонь
- Пожарный интерфейс
- Удалять водонепроницаемый приносить
- Пожарная сигнализация пресса
- Пожарная стойка
- Огневой пистолет
- Огневой пистолет
- Другое противопожарное оборудование
- Защита рук
- Медицинский перчатки
- Изоляция перчатки
- Долговечный высокая температура перчатки
- Низкая температура перчатки
- Антистатический перчатки
- Пожаротушение перчатки
- Сварщик перчатки
- Механический перчатки
- Предотвращать перчатки
- Одноразовые перчатки
- Анти -заканчивая перчатки
- Универсальная работа перчатки
- Другая защита рук
- Совместное производство защитного оборудования
- Защита тела
- Падать
- Установить полностью приносить
- Установить полностью веревка
- Другая падающая защита
- Окинава
- Молниезащита
- Молниеотводы
- Блоки питания молниезащиты
- Мониторинг молниезащиты, счетчики
- Другое молниезащитное оборудование
-
Пакеты, коробки и упаковка
- Пластиковая тара
- Пластиковые ящики
- Пластиковые стаканчики
- Пластиковые тюбики
- Пластиковые коробки
- Пластиковые бутылки
- Пластиковые банки
- Пластиковые канистры и ведра
- Другая пластиковая тара
- Полиэтиленовые пакеты и упаковка
- Пакеты в рулонах
- Эко пакеты
- Закрывающиеся пакеты
- Пакеты для покупок
- Пакеты Zip-lock
- Пакеты для одежды
- Другие полиэтиленовые пакеты
- Пакеты с ручками
- Пищевые пакеты
- Разные пакеты
- Почтовая и логистическая упаковка
- Вспененный полиэтилен
- Пленка на воздушной подушке, пузырьковая пленка
- Ящики из пенопласта
- Наклейки на посылки
- Защитный профиль из картона
- Логистика холодной цепи пакет Пакет
- Воздушные пакеты для бутылок
- Картонная упаковка
- Полиэтиленовые курьер-пакеты
- Мешки и сумки полипропиленовые
- Картонные коробки
- Упаковочный скотч
- Пакеты из пузырьковой пленки
- Пакеты с пузырьками MAIL LITE
- Печать коммерческой полиграфии
- Текстильная упаковка и сумки
- Сумки и мешочки из мешковины
- Багажные сумки и сумки для обуви
- Ткань для пошива сумок
- Изготовление промо-сумок на заказ
- Шелковые сумки
- Атласные сумки
- Другие текстильные сумки и упаковка
- Тканевые сумки для покупок
- Сумки без рисунка под печать
- Сумки и мешочки из хлопка
- Бархатные мешочки
- Сумки из полиэстера
- Марлевые сумки
- Стеклянные ёмкости и упаковка
- Другие стеклянные ёмкости и упаковка
- Оптовое изготовление упаковки из стекла
- Стеклянные бутылки, банки и колбы
- Стеклянные ёмкости для хранения
- Пищевая упаковка
- Упаковка для медицинских препаратов
- Упаковка для шоколадных конфет
- Упаковка для орехов
- Упаковка для лечебных сборов
- Упаковка для свежих овощей и фруктов
- Чистый карман
- Сосающий поднос
- С жемчужинами хлопок Яйцо
- Пластиковая яичная говядина
- Пакеты для еды на вынос
- Пакеты и упаковка для снеков
- Упаковка для злаков и лапши
- Упаковка для цукат и сухофруктов
- Водный кислородный пакет
- Другая пищевая упаковка
- Пакеты и коробки для выпечки
- Упаковка для одежды и обуви
- Упаковка для обуви
- Упаковка для нижнего белья
- Упаковка для носков
- Упаковка для детской одежды
- Упаковка для аксессуаров
- Упаковка для одежды
- Скотч и клейкая лента
- Специальная лента
- Транспортная автомобильная лента
- Строительный и малярный скотч
- Медицинские лейкопластыри
- Канцелярский скотч
- Технический скотч
- Скотчи для ремонта электроники
- Другая клейкая лента
- Экологичная клейкая лента
- Бумага для полиграфической продукции
- Художественная бумага
- Газетная бумага
- Офсетная бумага
- Мелованная бумага
- Бумага для печати книг
- Легкая книжная бумага
- Бумага с водяными знаками
- Другая печатная бумага
- Термобумага
- Рисовая бумага
- Термотрансферная бумага
- Копировальная бумага
- Коробочки и пакетики для аксессуаров
- Коробочки и упаковка для наручных часов
- Упаковка для шарфа
- Печать на заказ
- Упаковочная бумага
- Крафт бумага
- Бумага для печати визиток и карточек
- Калька
- Прокладочный картон
- Гофрированная бумага и гофрокартон
- Бумажные стаканчики и пакеты
- Специальная бумага
- Промасленная и влагостойкая бумага
- Целлофан
- Фольга
- Крепированная бумага
- Этикеточная бумага
- Ламинированная бумага
- Бумага для выпечки
- Другая упаковочная бумага
- Каменная бумага
- Изготовление упаковки на заказ
- Упаковка для ежедневных нужд
- Упаковка для сигар и сигарет
- Багажная упаковка
- Упаковка для книг
- Упаковка для домашнего текстиля
- Упаковка для автозапчастей
- Упаковка для игрушек
- Упаковка и тара для контактных линз
- Другая упаковка для повседневных нужд
- Изделия из бумаги
- Держатели и формы из целлюлозы
- Бумажные пищевые контейнеры
- Бумажные контейнеры
- Бумажные тубусы и трубки
- Другие изделия и ёмкости из бумаги
- Бумажные банки
- Бумажные пакеты
- Коробки и упаковка
- Бумажные стаканчики
- Сельское хозяйство пакет Пакет
- Фруктовая сумка
- Насекомое -сетчатая сетчатая сумка
- Размножение пакет Пакет
- Растение пакет Пакет
- Сельскохозяйственный продукт пакет Пакет
- Другое сельское хозяйство пакет Пакет
- Сумка для подачи удобрений
- Деревянные ёмкости и упаковка
- Деревянные ящики и контейнеры для перевозки
- Деревянные бочонки и ведра
- Бамбук пакет Пакет
- Другие деревянные ёмкости
- Деревянные подарочные коробочки
- Крышки, накладки, пробки
- Пластиковые крышки и дозаторы
- Резиновые накладки и уплотнители
- Ева пенка (Фоамиран)
- Пробки, накладки, уплотнители из пробки
- Упаковочные аксессуары
- Металлические крышки
- Тара и упаковка для напитков
- Упаковка для вина
- Другая тара и упаковка для напитков
- Упаковка для молока и молочных продуктов
- Тара для безалкогольных напитков
- Стеклянные бутылки
- Керамические емкости и упаковка
- Другие керамические ёмкости
- Керамические горшки и банки
- Керамические бутылки, кувшины и вазы
- Материалы для горячего тиснения
- Пленка горячего тиснения
- Фольга для горячего тиснения универсальная
- Электрохимический алюминий
- Фольга для горячего тиснения
- Голографическая фольга
- Матовая пленка для горячего тиснения
- Другие материалы для горячего тиснения
- Этикетки, наклейки, вывески, предупреждающие знаки
- Пластиковые и полиэтиленовые наклейки
- Другие этикетки и вывески
- Наклейки-этикетки
- Бумажные ярлыки
- Металлические таблички и указатели
- Лотки и поддоны
- Пластиковые поддоны
- Поддоны из прессованной бумаги
- Металлические поддоны
- Другие лотки и поддоны
- Деревянные поддоны
- Другое производство бумаги
- Целлюлозное сырье
- Соломенная масса
- Древесная масса
- Яйцо белый Пикхин
- Минеральная мякоть
- Тростника
- Разрыв
- Другое целлюлозное сырье
- Хлопок Суспений
- Тростник
- Бамбуковая мякоть
- Газетные волокна
- Солома
- Конопля
- Упаковочная пленка
- Электростатическая пленка, термоусадочная пленка
- Стрейч-пленка
- Фольгированная пленка
- Уплотнительная и упаковочная пленка
- Другая упаковочная пленка и материалы
- Защитная пленка
- Промышленная упаковка
- Упаковка для электронных компонентов
- Упаковка и чехлы для приборов
- Упаковочные материалы для химической промышленности
- Коробки для деталей и запчастей
- Металлические коробки, ёмкости и упаковка
- Другие металлические контейнеры
- Металлические ведра и бочки
- Металлические тюбики
- Другая металлическая упаковка
- Металлические банки
- Металлические сувенирные коробочки
- Упаковка для цифровой техники
- Упаковка для бытовой техники
- Упаковка для data-кабелей
- Упаковка и чехлы для наушников
- Водонепроницаемые чехлы для смартфонов
- Упаковка для ПК
- Сумки и упаковка для фотоаппаратов
- Упаковка для цифровых аксессуаров
- Зеленый Не вредит окружающей среде пакет Пакет
- Экологически чистые чернила пакет материал
- Лента -безжалона
- Мудрость пакет Пакет
- Взаимосвязан пакет Пакет
- Активный пакет Пакет
- Void/dr.lf и другие анти -закуски стандартный
- Совместное производство упаковки
- Макулатура и отходы производства
- Отходы отбеленной бумаги
- Оборудование для переработки отходов
- Европейские отходы
- Другая макулатура
- Веревки, стяжки
- Упаковочные ремни из пластика
- Другие веревки и стяжки
- Веревки
- Багажные ремни
- Упаковочные ремни резинки
- Полипропиленовые упаковочные ремни
- Кабельные стяжки
- Совместное производство бумажной продукции
- Совместное производство бумаги
- Промышленная бумага
- Фильтр-бумага
- Изоляционная бумага
- Производство различной бумаги
- Лакмусовая бумага
- Бумага с пропиткой
- Антикоррозийная бумага
- Другая промышленная бумага
- Упаковка и тара для косметических средств
- Бутылки и коробочки для уходовых средств
- Бутылочки и баночки для косметики
- Распылитель
- Нажмите на бутылку с головой насоса
- Титр бутылка
- Бутылка шланга
- Уход за кожей пакет материал
- База под макияж, косметичка
- Флакончики и баночки для путешествий
- Подарок пакет Пакет
- Упаковка для ювелирных изделий
- Упаковка и карточки для цветов
- Подарочная упаковка
- Мешок для подарков
- Упаковка для чая
- Рождественский подарок пакет Пакет
- Ручка пакет Пакет
- Парад Лодок-Драконов пакет Пакет
- Подарок на фестиваль середины пакет Пакет
- Косметика подарочная коробка пакет Пакет
- Напитки и подарки пакет Пакет
- Детская игра/детский подарок пакет Пакет
- Сельскохозяйственные и боковые продукты пакет Пакет
- Подарок на день рождения пакет Пакет
- Подарок на День святого Валентина пакет Пакет
- Новый год подарок пакет Пакет
- Подарок для здоровья пакет Пакет
- Подарки по ремеслам/Венвану пакет Пакет
- Бизнес подарок пакет Пакет
- Творческие подарки пакет Пакет
- Полиграфия, услуги печати
- Инструкции по эксплуатации
- Рекламная печать
- Визитная карточка печати
- Печать настольных календарей
- Печать календарей
- Печать книг и журналов
- Печать постеров и флаеров
- Печать бухгалтерских бумаг и журналов
- Другая бумажная полиграфическая продукция
- Печать визиток и карточек
- Меню
- Тайваньская карта/тайваньский
- Один В соответствии с/квитанциями
- Оборудование для изготовления упаковки по Консигнационному договору
- Композитная упаковка
- Другая бумага
- Пластик пакет Карман
- Другие пластиковые пленочные пакеты
- Не вредит окружающей среде пакет Карман
- Пластиковый мешок для жилета
- Пластиковая сумочка
- Пластиковый пакет для покупок
- Пластиковая самостоятельная сумка
- Пластиковый пакет
- Пластиковый независимый пакет
- Пластиковый пищевой пакет
- Пластиковая сумка для одежды
-
Оборудование, инструмент
- Измерение температуры и влажности
- Тепловой датчик измеритель
- Медицинский термометр
- Инструмент проверки температуры
- Термометр
- Термометр для жидкости
- Тепловизор
- Термометр дистанционный
- Термометр
- Контроль температуры и влажности(регулировать)Устройство
- Тепловая марионетка
- Термометр для гриля
- Другие инструменты температуры и влажности
- Бесконтактный термометр
- Инструмент для экологического тестирования
- Измеритель шума
- Газоанализатор
- Инструменты отбора проб пыли и воздуха
- Онлайн -монитор
- ROHS Обнаружение
- Инструмент обнаружения трески
- Озоновый детектор
- Дозиметр
- Измерение почвы PH
- Измерители
- Электромагнитное исследование стандартный Мандарин
- Ионизирующее излучение излучения стандартный Мандарин
- Механическое измерение веса
- Оптическое измерение стандартный Мандарин
- Химическое измерение стандартный Мандарин
- Время частота Мера стандартный Мандарин
- Тепловые измерения стандартный Мандарин
- Другое измерение стандартный Мандарин
- Механический счетчик
- Измерительный инструмент
- Скорость измерения прибора
- Крутящий момент
- Другие механические счетчики
- Скорость измерителя
- Для Инструмент
- Текстильный инструмент
- Другой для Инструмент
- Анализатор
- Монитор
- Еда, наркотик и полностью Тестирование оборудования
- Инструмент обнаружения бумаги
- Химический инструмент
- Электростатический тестер
- Детектор ЭКГ
- Земля и горнодобывающие инструменты
- Вибрационный счетчик
- Судовой инструмент и инструмент
- Установить полностью инструмент
- Гидрологический инструмент
- Ограничитель крутящего момента
- Асфальтовый тестовый прибор
- Инструмент обнаружения связи
- Дальномер
- Электрический прибор
- Наступительный
- Прибор измерения сопротивления
- Машина для ремонта батареи
- Частота измерять
- Параметр испытательный прибор
- Мост
- Потенциальный счетчик
- Коробка сопротивления
- Контроллер коэффициента мощности
- Мультиметр
- Инструмент измерения напряжения
- Другие электрические инструменты
- Тестер батареи
- Тестовый карандаш
- Ток измерения прибора
- Электрический инструмент
- Прибор измерения мощности
- Балансировщик
- Земля
- Платформа шкала
- Пояс шкала
- Висящие весы
- Ингредиент
- Количественная шкала
- Орбиталь
- Ценовая шкала
- Другой баланс
- Электронная шкала
- Электронный измерительный прибор
- Икона
- Сильный инструмент
- Медицинский электронный инструмент измерения
- Компонентный тестер
- Частота Спектр -анализатор
- Измеритель измерения параметров
- Генератор сигналов
- Измерительный прибор LCR
- Осциллограф
- Другие электронные измерительные инструменты
- Оптические инструменты
- Рефрактор
- Amatalize зеркало Объект зеркало
- Фильтр, цветовой фильтр
- Спектрометр
- Иллюминометр
- Разница в цвете
- Спагетт
- Температура плавления
- Ультрафиолетовое излучение
- Вмешательство
- Поляризация зеркало , UV зеркало
- Оптический детектор
- Стольская световая занавес
- Отражение зеркало
- Промышленный сканер
- С проекцией Инструментальный аксессуар
- Спектрохемометр
- Промышленная камера
- Оптическое оборудование и аксессуары
- Другие оптические инструменты
- Ночное видение
- Долгое время зеркало
- Увеличить зеркало
- Микро зеркало
- Проектор
- Край зеркало ,через зеркало
- Оптическое фотооборудование
- Штатив
- Фотография фон
- Оптическая камера
- Склейка камера
- Студия
- Напечатано цвет Устройство расширения
- Другое фотооборудование
- Зеркало голова
- Экспериментальное приборное устройство
- Другие экспериментальные приборные устройства
- Ареометр
- Титр
- Поза
- Баланс инструмент
- Вакуумный инструмент измерения
- Метр тепла
- Учебный инструмент
- Поток инструмента
- Расходомер
- Водомер
- Газомер
- Дроссельное устройство
- Устройство проверки
- Другие транспортные инструменты
- Стрессовый инструмент
- Манометр
- Инструмент проверки давления
- Контроллер давления
- Другие инструменты давления
- Дифференциальное давление давления
- Декомпрессия
- Манометр
- Инвентарный инструмент и инструмент
- Пакет Установочное испытательное оборудование
- Детектор утечки
- Сжатая тестовая машина
- Политируемость тестовая машина
- Другой пакет Установочное испытательное оборудование
- Инструмент
- Жидкий уровень переключатель
- Жидкость
- Магнитный панель Жидкость
- Радар Метр
- Ультразвуковой
- Емкость
- Плавучий измеритель уровня жидкости
- Контроллер уровня плавающего шарика жидкости
- Контроллер ингредиента
- Другие объекты
- Стекло панель Жидкость
- Тестовая коробка и оборудование для климатической среды
- Оборудование для испытаний
- Коррозионная испытательная коробка
- Высокая Низкий термометр
- Сушильная коробка
- Старение коробки
- Влажная и влажная испытательная коробка
- Прибор для испытательного тумана соль
- Другие испытательные ящики и климатическое оборудование
- Оборудование для обнаружения парового мотоцикла
- Другое испытательное оборудование
- Позиционер
- Таблица обнаружения
- Анализатор
- Детектор
- Диагноз
- Испытательный стенд
- Поток инструмента
- Водомер
- Расходомер
- Другие транспортные инструменты
- Устройство проверки
- Дроссельное устройство
- Газомер
- Оптическое оборудование камеры
- Другое оборудование для камеры
- Нулевой белый Видеозапись
- Рекордер
- Оптическая камера
- Подходящая часть инструмента и инструмента
- Панель приборов
- Приборная коробка
- Приборная коробка
- Используйте источник питания
- Другие инструменты и инструменты соответствуют деталям
- Оболочка прибора
- Промышленное таймер
- Другие инструменты
- Без Инструмент обнаружения ущерба
- Другой без Инструмент обнаружения ущерба
- Детектор покрытия
- Заглядывая зеркало
- Утечка
- Царапать
- Тестер шероховатости
- Ультразвуковой детектор
- Измерение толстая инструмент
- Тестирование машина
- Балансировщик
- Тестер твердости
- Другие тестовые машины
- Стресс -тестовый машина
- Испытательная машина сгибания
- Машина для тестирования усталости
- Износ -устойчивый
- Тестовая машина сброса
- Тестовая машина интенсивности
- Тестовая машина на растяжение
- Вибрационная тестовая машина
- Обратная тестовая машина
- Impact Test Machine
- Универсальная тестовая машина
- Нет металлический Материал тестовой машины
- Тестовая машина ремесла
- Материал тестовой машины
- Прибор индекса плавления
- Детектор власти и деформации
- Пакет Установочная тестовая машина
- Автомобильное испытательное оборудование
- Прилавок
- Инструмент науки о жизни
- Другие инструменты науки о жизни
- Инструмент анализа жидкости крови и тела
- Встряхивая кровать, осциллятор
- Биомедицинский анализатор
- Ферментер
- Замороженная сушилка
- Низкотемпература холодильника
- Средний
- Инструмент расширения, ПЦР -инструмент
- Фермент стандартный Увеличить, мыть панель машина
- Реактор
- Тренировочная коробка
- Биохимический электрический
- Клеточная дробилка
- Прибор для обнаружения микробов
- Стерилизатор
- Супертете Workbench
- Извлекать
- Фильтр и ультрафильтрационный инструмент
- Экспериментальный инструмент для животных и растений
- Инструмент генетического тестирования и обработки
- Автоматическая Устройство
- Контроль(регулировать)метр
- Автоматическая Емкость система
- Исполнительное агентство
- Другой автоматическая Проверенный счетчик
- Концентрированное управляющее устройство
- Электрический один Юань комбинированный инструмент
- Пневматический один Юань комбинированный инструмент
- Подвал инструмент
- Инспекционный инструмент
- Установить полностью Стойка
- Рубма для Инструмент
- Другой резиновый и пластиковый для Инструмент
- Пробоотборник
- Victoria Softener Testor
- Сульфид
- Хроматограф
- Хроматографическая рабочая станция
- Газовый хроматограф
- Жидкая хроматография
- Ионо -цветовой спектрометр
- Хроматографическая колонка
- Пробоотборник
- Другая хроматография
- Метеорологический инструмент
- Автоматическая Метеорологическая станция
- Инструмент направления ветра ветра
- Другие погодные инструменты
- Воздушный »
- Затвор
- Rainometer
- Депотичный
-
Бытовая техника
- Товары для здоровья
- Массажеры для головы
- Электрическая наклейка массажа
- Электрический массажер
- Электрические ноги
- EMS Massager
- Брюшная полость
- Электрический прибор для соскоб
- Электрическое колено корпус Массаж
- Электрическое обезжиренное устройство
- Аппарат для измерения жира
- Аппараты для коррекции фигуры
- Аппараты для похудения
- Лечебные массажеры для ног
- Электрический нагревающий дворцовый ремень
- Умный приток
- Массажные чехлы
- Оборудование для ухода за глазами
- USB-массажеры
- Оборудование для сауны
- Умный сон
- Аксессуары для ремонта аппаратов для красоты и здоровья
- Пояса с подогревом
- Домашние сауны
- Мини массажеры
- Массажные подушки
- Другие массажеры
- Фасция
- Аппараты для ухода за ногами
- Массажные пояса
- Педикюрная ванночка для ног
- Ручные массажеры
- Массажеры для глаз
- Массажные кресла
- Массажные накидки на плечи
- Шейный счетчик/шейный массаж
- Системы умный дом
- Материнские и младенческие приборы
- Соплеотсос
- Чайники и термосы для приготовления детской смеси и молока
- Приборы для стрижки младенцев
- Другие устройства для безопасности ребенка
- Радио-няни
- Стерилизаторы и подогреватели молока
- Обработка бытовых приборов
- Совместная разработка оборудования для дома
- Домашние медицинские приборы(инструмент)
- Кислород(инструмент)
- Помогите лектору(инструмент)
- Домохозяйство Metaidae(инструмент)
- Домашний распылитель(инструмент)
- Слуховой аппарат(инструмент)
- Увеличение груди(инструмент)
- Лазерный физиотераперов(инструмент)
- Голова/талия/шея/ноги(инструмент)
- Стоматологический(инструмент)
- Необработанный(инструмент)
- Электротерапия(инструмент)
- Нагревание паровая инструмент(инструмент)
- Шея(инструмент)
- Инструмент для сна(инструмент)
- Электронная физиотерапевтическая наклейка(инструмент)
- Рекреационный инструмент(инструмент)
- Стрелять частота инструмент(инструмент)
- Электрическое явление(инструмент)
- Интеллектуальная реабилитационная площадка(инструмент)
- Электрический прибор для соскоб(инструмент)
- Сильный инструмент удаления пульса(инструмент)
- Техника для кухни
- Электрочашки, электротермосы
- Мультиварки
- Соковыжималки
- Коробки для обеда с подогревом
- Кипятильники
- Микроволновые печи
- Скороварки
- Домашний завтрак
- Керамические варочные панели
- Портативные рисоварки
- Йогуртницы
- Блендеры
- Другая мелкая бытовая техника
- Системы очистки воды
- Портативные соковыжималки
- Электросковороды
- Электрочайники
- Электрические фритюрницы
- Мультиварки и рисоварки
- Индукционные варочные панели
- Аксессуары для ремонта кухонной техники
- Аксессуары для систем очистки воды
- Мороженица
- Электробарбекю
- Тостеры, вафельницы и приборы для приготовления завтрака
- Сэндвичницы-гриль
- Обеденные столы с подогревом
- Сокоохладители
- Кофеварки, кофемолки и кофемашины
- Кипящий горшок
- Паста-машины
- Миксеры
- Чайная машина
- Домашний воздушный фритюрник
- Сигарный шкаф с постоянной температурой
- Домашняя стена
- Стерилизовать
- Многофункциональная посудомоечная машина
- Домашний электрический пароход
- Индукционные плиты для чайной церемонии
- Электрический чай
- Электроплитки
- Термопоты
- Домашний электрический шабу -шабу
- Приготовленная на жареной машине
- Хлебопечки
- Измельчители льда
- Электрические духовки
- Аппараты для варки пива и вина
- Яйцеварки паровые
- Домохозяйственная машина
- Умная стерилизация палочки для еды
- Молочная машина
- Домашняя овощная машина
- Маслопрессы
- Проращиватели
- Машины для соевого молока
- Пароварки
- Глиняные электрогоршочки
- Ледогенераторы
- Ледоизмельчители
- Электровоки и мультиварки-скороварки
- Холодильник
- Чашки для яиц
- Автоматическая верх Водонагреватель
- Электрический портативный кулер
- Kidtoper
- Домашний электрический горшок
- Постоянная температурная монета
- Машины для детоксикации фруктов и овощей
- Чайники для заварки чая и трав
- Домохозяйство по сохранению продуктов питания
- Аудио и видео техника
- Эхо-динамики
- Аккустические системы
- Смарт-динамики
- Bluetooth колонки
- Микрофоны
- Аудио и видео аксессуары
- Магнитолы
- Другие динамики
- Другая аудио и видео техника
- Домашние кинотеатры
- Портативные динамики и радио
- Автомобильный видеоплеер
- Виниловые проигрыватели
- Громкоговоритель
- CD проигрыватели
- Другие аудио уствойства
- Усилители
- К Гебао
- Вида
- Игрок
- Провода
- Дисковые проигрыватели в авто
- Телеприставки
- Умный переводчик
- Бытовые приборы
- Фильтры и аксессуары для очистителей воздуха
- Сушилки для рук
- Роботы-пылесосы
- Увлажнители воздуха
- Другие бытовые приборы
- Аксессуары для бытовых приборов
- Пылесосы
- Очистители воздуха
- Парогенераторы
- Портативные пылесосы
- Машинки для удаления катышков
- Арома-диффузеры
- Ультразвуковые очистители
- Прибор для очистки ковров от клещей и насекомых
- Сушилки для белья
- Утюги
- Промыть
- Кулеры и диспенсеры для питьевой воды
- Паровые швабры
- Умный мусор
- Роботы для чистки окон
- Пароочистители ручные
- Электронный продукт дезинфекционер
- Дозаторы для жидкого мыла
- Сканирующий робот
- Умное охлаждение удерживающий тепло чашка
- Портативный дозатор воды
- Настольная чистящая машина
- Осушители воздуха
- Промышленные пылесосы
- Косметика холодильника
- Дезинфекция нижнего белья
- Одежда
- Домохозяйственная машина для производства
- Электронное устройство охлаждения продукта
- Альдегиды
- Партнер -кондиционирование Smart Air
- Дом дезинфекция палка
- Устройство для приучения к горшку ночью
- Электрическая швабня
- Со складыванием стиральная машина
- Полотенцесушители
- Машина по очистке дивана/ткань/ткань/ковры
- Измельчители пищевых отходов
- Климатическая техника
- Одеяла, грелки и матрацы с подогревом
- Уничтожители комаров
- Безлистный вентилятор
- Потолочные вентиляторы
- USB-вентиляторы, мини-вентиляторы
- Тепловые пушки
- Мини-вентиляторы
- Конвекционные вентиляторы
- Уничтожители комаров
- Вентиляторы
- Отпугиватели насекомых и грызунов
- Сушилки для обуви
- Вентилятор-кондиционер
- Другая техника для обогрева
- Коврики на рабочий стол с подогревом
- Наружный комар свет /Mosquito Wizer
- Фанат кемпинга
- Другие вентиляторы
- Аксессуары для ремонта и монтажа климатической техники
- Промышленные вентиляторы
- Теплое одеяло
- Вода -плавное одеяло
- Грелки для ног
- Другая техника для лета
- Портативные грелки для рук
- Грелки
- Электро-одеяла
- Холодно и тепло
- Электрическое отопление
- Крупная бытовая техника
- Водонагреватели электрические
- Стиральные машины
- Детали для установки и ремонта кондиционеров
- Детали для установки и ремонта телевизоров
- Детали для установки и ремонта стиральных машин
- Телевизоры
- Электронные смесители
- Холодильники
- Аксессуары для вытяжек
- Детали для ремонта холодильников
- Газовые варочные панели
- Дезинфекционные шкафы
- Вытяжки в ванную комнату
- Детали для установки и ремонта кухонной техники
- Водонагреватели на солнечных батареях
- Кондиционеры и сплит-системы
- Стиральная машина с стеной
- Мини -холодильник
- Встроенная микро духовка
- Морозильные камеры
- Электронные шкафы для хранения вина
- Другие водонагреватели
- Встраиваемые вытяжки со светильниками
- Другая техника для кухни и ванной
- Другая бытовая техника
- Вытяжки
- Варочные панели с вытяжкой
- Посудомоечные машины
- Водонагреватели для кухни
- Водонагреватели с электронным управлением
- 3D телевизор
- AR TV
- Зарядка холодильника
- Детали для монтажа кухонной техники
- Холодная коробка дома
- Домашняя сушилка
- Встроенная микроволновая печь
- Стирать комплект
- ЖК -телевизор
- Лазер
- Газовые водонагреватели
- Телевизионный кронштейн
- Воздушный водонагреватель с тепловым насосом
- Плазменное телевидение
- Touch TV
- Техника для красоты и здоровья
- Другие аппараты для коррекции фигуры
- Ультразвуковые приборы для лица
- Электрические шапки-грелки
- Щипцы для выпрямления и завивки
- Аппараты домашней косметологии
- Электрические зубные щетки
- Электробритвы
- Другие аппараты домашней косметологии
- Эпиляторы и триммеры
- Машинки для стрижки волос
- Корсеты для исправления осанки
- Фены для волос
- Увлажнители для лица
- Приборы для механической чистки лица
- Аппараты для чистки лица
- Утяжки для лица
- Аксессуары техники для красоты и здоровья
- Электропилки для ног
- Триммеры
- Дезинфекция зубной щетки
- Отбеливание зубов
- Аппараты для чистки пор
- Коммерческий инструмент красоты(Несоооооооооооооооооооооооооооо)
- Ирригаторы
- Аппараты для увеличения груди
- Электрическая шлифовальная броня
- Аппараты для удаления веснушек, угрей и пятен
- Приборы для чистки пор
- Лопата
- Электрический меч с бровью
- Лапша накладка Красотный инструмент
- Лед
- Маски для лица
- Восковая терапевтическая машина/портативная машина
- Родившийся инструмент и карьера для волос
- Электрические ресницы кудри
- Электрическая парикмахерская
- Электрические волосы
- Уход за кожей зеркало
- Красивый глаз
- Фотонковое устройство
- Массаж лица
- Электрическая ванна
- Окружающая моль инструмент
- Инъекция кислорода
- Шея
- Глаз
- Тестер кожи
- Стоматологический
- Электронный пероральный распылитель
- Скальп верх Подушка
- Стрелять частота инструмент
- Электрический зуд
- Запчасти для авто- мото- техники
-
Ремонт и интерьер
- Сантехника и мебель для ванной комнаты
- Ванны
- Шкафы для ванной
- Зеркала
- Умывальники
- Унитазы
- Электронные унитазы
- Прочая сантехника и аксессуары
- Писсуары
- Раковины для мытья швабр
- Дверцы и перегородки для душевой
- Электронные стульчаки
- Мобильный туалет
- Зеркала
- Тумбы под стиральную машину
- Раковины
- Стульчаки
- Туалетный распылительный пистолет
- Напольный унитаз
- Сливные бачки
- Ванная комната зеркало Комбинация шкафа
- Электронные биде
- Подъюбники
- Офисная служба оформления
- Служба отделки магазина
- Семейное жилое украшение
- Мебель для ресторанов
- Барные стойки
- Винные холодильники
- Обеденные стулья
- Обеденные столы
- Наборы столов и стульев в обеденную зону
- Тележки для официантов
- Шкафы и тумбы
- Карточное сиденье
- Молочный чайный стол
- Бар
- Промышленные кухонные столы
- Обеденный стол и стул в кафетерии
- Электромагнитная плита обеденный стол
- Стеновый обеденный стол
- Кофейный столик
- Остров
- Таблица лобстеров
- Верх Пищевой стол
- Ресторан диван
- Мебель для спальни
- Стулья для туалетных столиков
- Другая мебель для спальни
- Кожаная кровать
- Smart-кровати
- Другие шкафы
- Гардеробы
- Палм -весна матрас
- Кровати из массива дерева
- Тумбочки
- Туалетные столики
- Комоды
- Ограждения для детских кроватей
- Латекс весенний матрас
- Шкафы с антресолью
- Кровати с подъемным механизмом
- С ветром окно шкаф
- Другие кровати
- Кровать ротанга
- Шкаф
- Потягивающая кровать/кровать полки
- Кровать/кровать панель
- Кровать хвост табуретка
- Комбинированный взрыв
- Чемодан
- Прикроватный столик
- Матрацы
- Круглый матрас
- 3D матрас
- Рулон пакет / со складыванием Матрас
- Память хлопок Весенний матрас
- Эротическая мебель
- Сантехническое оборудование
- Кранбуксы
- Баттон, Смеситель для душа
- Кран
- Душ
- Прочая сантехника
- Кухня
- Душ комплект
- Шаровые краны
- Краны
- Душ и аксессуары
- Душевые шланги
- Напольные сливы
- Смесители
- Радиаторы
- Сливы для раковин и ванн
- Угловые краны
- Быстрое лидер
- Водоотделители
- Промывочные клапаны
- Клапанные пластины
- Панели и смесители для душевой
- Строительные проекты
- Простая мебель
- Заправка зеркало
- Другие полки
- Книжная полка
- Табуреты
- Складные табуреты
- Пуфы с ящиком
- Простые обувные шкафы
- Полки для вина
- Полки
- Полки для обуви
- Подставки под цветы
- Подвесные полки
- Напольные вешалки для одежды
- Скамейки и табуреты для смены обуви
- Складные столы
- Кровати раскладушки и трансформеры
- Напольные зеркала
- Ленивый диван
- Складные стулья
- Простые полки, тумбы
- Пластиковые столы и стулья
- Раскладные компьютерные столы
- Складные кресла
- Обувные полочки и приспособления для хранения
- Простые шкафы
- Садовые столы и стулья
- Подставки под цветы
- Надувные подушки
- Садовые деревянные столы и стулья
- Наружный диван
- Висящая корзина/подвесное кресло
- Столы для игры в маджонг
- Уличные зонтики
- Игровые столы
- Шезлонги
- Подвесные стулья
- Надувные диваны
- Кресло-качалки
- Ротанговые столы и стулья
- Надувные кровати
- Садовые складные столы и стулья
- Садовые металлические столы и стулья
- Детская мебель
- Рабочие столы и стулья
- Детские диван
- Детские кровати
- Деревянные детские кровати
- Детские тумбы
- Детские шкафы
- Детские обувные полки, шкафы
- Детские вешалки
- Детские обеденные стулья
- Детские кресло-качалки
- Другие учебные пособия
- Стеллажи и комоды для детской комнаты
- Стулья для кормления
- Детские столы и стулья
- Кровати
- Детские рабочие столы и стулья
- Детские табуреты
- Колыбели и качалки
- Детские книжные полки, шкафы
- Детские полки
- Детские кровати
- Покрытия на стены
- ПВХ обои
- Мягкий пакет
- Фреска
- Настенная ткань
- Обои
- Древесина и стройматериалы из дерева
- Декоративные панели
- Фанера
- Пластик с имитацией дерева
- Древесина
- Деревянные бордюры и плинтуса
- Деревянный профиль
- Деревянная стружка панель
- Приклеен панель
- Средний плотный волокно панель
- Другие стройматериалы из дерева
- Доски
- Мебельная фурнитура, аксессуары
- Мебельный рельс
- Ножки и стойки мебельной фурнитуры
- Ручки и петли мебельной фурнитуры
- Ручки для мебели и дверей
- Мебельный шарнир, шарнир
- Камень
- Песок, гравий, галька
- Искусственный камень
- Каменные плиты, панели
- Гранит
- Песчаник
- Средства по уходу за камнем
- Другой камень
- Мрамор
- Гипсовый кладочный раствор
- Напольное покрытие
- Другие виды напольного покрытия
- Ламинат и пластиковое покрытие
- Подкрепление панель
- Доска массив для пола
- Паркетные доски
- SPC Stone Plastic Land панель
- Деревянный пластик панель
- Резиновое покрытие
- Бамбуковое покрытие для пола
- Стальное покрытие
- Смеси для наливных полов
- Земля панель Приложение
- Сырье для напольного покрытия
- ПВХ панель
- Двери
- Створчатые окна
- Раздвижные ограждения и внешние двери
- Окна
- Раздвижные двери
- Двери купе
- Раздвижные окна
- Фиксированные окна
- Складные окна
- Висячие окна
- Другие окна
- Изготовление окон на заказ
- Складные двери
- Ротационные двери
- Рольставни
- Другие наружные двери
- Без рамка окно
- Войдите в домашнее хозяйство дверь
- Стеклянные веранды
- Накладки на уголки мебели
- Мягкие наклейки на мебель
- Двери и перегородки
- Накладки на двери
- Распашные двери
- Манежи и ограждения для комнат и лестниц
- Функциональный материал
- Теплоизоляция
- Огнеупорный материал
- Звукоизоляция и звукопоглощающие материалы
- Водонепроницаемый, влагостойкий материал
- Изоляция и изоляционные материалы
- Фурнитура для дверей и окон
- Уплотнители для дверей и окон
- Аксессуары для дверей и окон
- Упоры и ограничители для дверей
- Дверные и оконные крюки
- Шпингалеты, задвижки
- Напольные скрытые доводчики
- Зажимы монтажные для дверей
- Гвозди
- Магниты, магнитные полосы
- Профили дверные, оконные
- Алюминиевые распорки
- Шкивы дверные, оконные
- Аксессуары для штор
- Ручки
- Дверные петли и шарниры
- Направляющие для раздвижных механизмов
- Глазки
- Коммерческая, офисная мебель
- Аптечные шкафы
- Рядные стулья, кресла ожидания
- Встреча встреч
- Парикмахерские кресла
- Игровой стол
- Парикмахерские зеркала
- Тренировочный стол
- Школьный подиум
- Подъемный стол
- Диван -карта
- Горячий горшок
- Бар
- Отель мебель
- Мебель для питания/выпечка
- Телефонная будка
- Трибуны
- Тренер
- Интернет-кафе
- Офисные перегородки для рабочего стола
- Ноготь
- Кормление
- Реабилитационный кресло
- Экран для ухода
- Развлечения/бар/KTV мебель
- Приемное кресло
- Пианино
- Цветочные ящики
- Рабочий стол
- Офисные столы
- Офисные столы угловые
- Компьютерные столы
- Барные стулья и табуреты
- Офисные столы многоместные
- Игровое кресло
- Мойки для волос
- Металлические кровати
- Офисные диваны
- Массажные столы
- Офисные шкафы
- Офисные, компьютерные стулья
- Кресла для руководителя
- Учебное кресло
- Потолки
- Другие панели и материалы для крепежа
- Натяжные потолки ПВХ
- Профили
- Алюминиевые реечные подвесные потолки
- Соты панель
- Светильники и вентиляции в потолок
- Потолочные панели с рустом
- Потолочные панели из минерального волокна
- Закрытие полосатый
- Потолочный гипсокартон
- Лестницы, лифты
- Лифт и аксессуары
- Другие лестницы и оборудование
- Лестницы и аксессуары
- Декоративные плинтуса и панели из пластика
- Декоративные панели
- Другие декоративные плинтуса и панели из пластика
- Бордюры для наружного дизайна
- Крепления для зеркал
- Плинтуса и панели
- Замки
- Навесные замки
- Замки на магнитной карте
- Оконные замки
- Замки для мотоциклов
- Замки для багажа
- Замки на IC карте
- Магнитные замки
- Другие замки
- Электронные замки
- Сенсорные замки
- Механические дверные замки
- Мебельные, офисные замки
- Аксессуары для замков
- Кодовые замки
- Замки для велосипедов
- Оформление ландшафта
- Заборы и оградки
- Бытовки
- Павильоны
- Ландшафтные проект
- Другие ландшафтные материалы
- Ландшафтный камень
- Фигуры из камня
- Стальные навесы
- Пейзажные скульптуры
- Фонтаны
- Трубопроводные системы
- Вентиляция
- Системы водоснабжения
- Трубы для водопроводных систем
- Газовые системы
- Дренажные системы
- Арматура для трубопроводов
- Другие трубопроводные системы
- Керамическая плитка
- Кирпич для внутренней отделки
- Камень панель
- Привязанность плитки
- Кирпич для наружных стен
- Другие плитки
- Напольная плитка
- Трубопроводная арматура
- Тройник
- Компенсаторы
- Крестовина
- Редукторы
- Колено
- Заглушки
- Фланец
- Заглушки для цистерн, труб и бочек
- Другие фитинги
- Строительный клей
- Клей для плитки
- Клей для камня
- Клей для дерева
- Клей для металла
- Клей для штор
- Клей для обоев
- Другие строительные клеи
- Клей для стекла
- Мебель для рабочего кабинета
- Книжные шкафы, полки
- Мебель на заказ
- Кухонные шкафы
- Кухонная мебель
- Кухонные столешницы
- Настенные шкафы
- Напольные шкафы и тумбы
- Емкости для хранения риса
- Буфеты и шкафы для посуды
- Полностью Настройка дома
- Гардеробные комнаты
- Татами
- Другая кухонная мебель и аксессуары
- Другие строительные материалы
- Чертежи для дома, дачи, виллы
- Почтовые ящики для многоквартирных домов
- Витражное стекло
- Аренда и покупка зданий для фабрики
- Фермы
- Горные домики
- Магазины
- Земля
- Офисы
- Другая недвижимость
- Камины
- Отопительные котлы
- Кровельные материалы и навесы
- Поликарбонат
- Шифер
- Аксессуары для навесов и тентов
- Тканевые навесы и шатры
- Другая мебель для ресторанов
- Другие комплекты мебели
- Комплекты мебели
- Полный набор мебели
- Переодельный столик+туалетный стул
- Стол+обеденный стул
- Крыльца терраса+ дверь Шкаф в холле+плащная стойка
- Дверь Шкаф для зала+шкаф для обуви
- Разделение+шкаф для обуви
- Диван+журнальный столик
- Диван+журнальный столик+телевизионный шкаф
- Диван+журнальный столик+телевизионный шкаф+угол
- Диван+угол
- Столовый стул+обеденный шкаф
- Столовый стул+винный шкаф
- Столовый стул+боковой шкаф+винный шкаф
- Двуспальная кровать+тумба
- Один Человеческая кровать+прикроватная стола
- Zi Mother Bed+Writing слово стол
- Двуспальная кровать+тумбочка+гардероб
- Один Человеческая кровать+прикроватный стол+гардероб
- Zi Mother Bed+Writing слово Таблица+гардероб
- Двуспальная кровать+кровабоковая стола+туалетный столик
- Один Человеческая кровать+прикроватная стола+туалетный столик
- Двуспальная кровать+кровабоковая стола+туалетный столик+гардероб
- Один Человеческая кровать+прикроватная стола+туалетный столик+гардероб
- Стол+письменность слово стул
- Стол и стул+книжный шкаф
- Стол и стул+книжный шкаф+ для отдыха диван
- Метовой столик+телевизионный шкаф
- Кухонная и ванная утварь
- Мыльницы
- Выдвижные ящики, стойки и корзины
- Диспенсеры для мыла
- Подставки и полочки для ванной комнаты
- Держатели для полотенец
- Аксессуары для раковины
- Держатели, перила и поручни для ванной
- Комплекты держателей и полок для ванной и кухни
- Туалет
- Другая утварь для кухни и ванной
- Раковины из нержавейки
- Раковины с решетками
- Мебель для гостиной
- Угол/сторона
- Столы для чайных церемоний
- Напольные полки
- Журнальные столики
- Другие стулья, табуретки и кушетки
- Тканевый диван
- Софы и мебель с тканевой обивкой
- Шкафчики для обуви
- Диван
- Кожаный диван
- Тумбы под телевизор
- Твердый деревянный диван
- Мебель для зонирования гостиной
- Диван кровать
- Железный диван
- Кожаный диван
- Лоза/бамбук диван
- Функциональный диван
- Таблица приема
- Угловой шкаф
- Межкомнатные резные перегородки
- Полосатый случай
- Дверь Зал/крыльцо/крыльцовая рама
- Подставки для ног
- Низкий табурет
- Держатели для CD дисков
- Резные ставни и рамы на окна
- Корневая мебель
- Стул
- Ручка
- Стул
- Маленькие столики
- Табуреты в форме барабанов
- Тахта
- Китайские кровати
- Алтари
- Стойки и подставки для статуи Будды
- Другая мебель для гостиной
- Firefall рама/каминный шкаф/отопление накладка
- Тематическая КАТЕГОРИЯ Новинки
- Оборудование
-
Poizon
- Спортивная обувь
- Кроссовки
- Велосипедки
- Для бадминтона
- Скалолазание
- Баскетбольные кроссовки
- Детская тренировочная обувь
- Обувь для открытого воздуха
- Стильная обувь для скейтбординга
- Обувь для походов
- Детская футбольная обувь
- Обувь для тренировок
- Обувь для скейтборда
- Винтажные баскетбольные кеды
- Детские баскетбольные кеды
- Детская утепленная обувь
- Модные кроссовки и повседневная обувь
- Бутсы
- Обувь для гольфа
- Обувь для малышей
- Рабочие ботинки
- Обувь для тенниса
- Детская обувь для скейтбординга
- Детские кроссовки
- Одежда
- Спортивные штаны
- Бюстгальтер
- Пижамные штаны
- Штаны
- Камизолы, топы
- Бюстгальтеры без бретелек
- Леггинсы
- Толстовки
- Жилеты
- Ханфу
- Шорты
- Термобелье
- Кожаные длинные юбки
- Свитера
- Майки, поло
- Брюки с карманами
- Колготки
- Куртки, пуховики
- Пиджаки
- Ветровки
- Меховые изделия
- Платья без рукавов
- Спортивные штаны
- Велосипедные костюмы
- Теннисные наряды
- Пляжная одежда
- Ночные рубашки
- Брюки от костюма
- Водолазки
- Кожаные штаны
- Куртки
- Кожаная куртка
- Пальто
- Солнцезащитная одежда
- Парка Коутс
- Джинсовая одежда
- Случайные штаны
- Носки
- Майки, топы
- Боди
- Рубашки
- Теплые спортивные штаны
- Пуховики
- Бейсбольные куртки
- Гоночные костюмы / костюмы мотоциклов
- Юбки
- Случайные длинные юбки
- Куртки и пальто
- Ветровки
- Пиджаки
- Куртки женские
- Пальто
- Жилеты
- Солнцезащитная одежда
- Футболки
- Дождевик
- Короткие юбки
- Платья для девочек
- Loungewear & нижнее белье
- Случайные штаны
- Пижама наборы
- Нижнее белье
- Корректор
- Куртки
- Тренчи
- Плащ
- Бархатные куртки
- Платья с длинными рукавами
- Короткие шорты
- Вечернее платье
- Толстовки и Кофты
- Трусы
- Брюки-карго
- Боксерские трусы
- Носки низкие
- Боди для спорта
- Шатровые штаны
- Баскетбольные носки
- Обрезанные пальто
- Обтягивающие платья
- Случайные шорты
- Случайные короткие юбки
- Длинные юбки
- Одежда для легкой атлетики
- Спортивные штаны
- Носки средние
- Высокие носки
- Халат для бани
- Теплые подштанники
- Мадре
- Аксессуары нижнего белья
- Куртки пуховики
- Бейсбольные майки куртки
- Бархатные куртки
- Тренчи
- Платья с короткими рукавами
- Случайные шорты
- Юбки пойзон
- Кожаные короткие юбки
- Комбинезоны и наборы
- Активная одежда
- Корсет
- Loungewear Компания
- Гидрокостюмы
- Вниз куртки и пальто
- Аксессуары
- Кожаные ремни
- Платки
- Шелковые шарфы
- Другие ремни
- Связи
- Запонки
- Учебные дела
- Заколки для волос
- Ключевые мешочки
- Комбо -наборы
- Аксессуары для наушников
- Европейские / американские часы
- Карманные часы
- Жадеитские браслеты
- Будильники
- Неклеты
- Рамки для очков
- Ведро шляпы
- Другие перчатки
- Вязаные перчатки
- Лыжные перчатки
- Другие аксессуары
- Талия цепочки
- Другие аксессуары для волос
- Вырезанные нефритовые украшения
- Швейцарские армейские ножи
- Жадеитские браслеты
- Смотреть корпус
- Браслеты
- Деревянные браслеты
- Ловцы шляпы
- Мешочки для мобильного телефона
- Ювелирные аксессуары
- Аксессуары для телефона
- Другие гетианские нефриты
- Мешочки для очков
- Плековые ремни
- Золотой браслет
- Нефритовые браслеты
- Солнечные очки
- Бейсболки
- Береты
- Кольца
- Серьги
- Клавицы
- Спортивные перчатки
- Броши
- Сумки для туалетных принадлежностей
- Завязывание волос
- Заколки для волос
- Шнурки
- Жемчужные броши
- Другие жадиты
- Смотреть группы
- Китайские часы
- Смотреть намотчики
- Смотреть чехлы
- Браслеты
- Браслеты
- Браслеты
- Прекрасные нефритовые браслеты
- Гетианские нефриты браслеты
- Жадеитские браслеты
- Жемчужные браслеты
- Настольные часы
- Солнечные маски
- Непрерывные очки
- Шапочки
- Перчатки
- Очки
- Ремни
- Другие деревообразные
- Гетианские нефриты браслеты
- Другие аксессуары
- Нефритовые браслеты
- Другие очки
- Капюшоны и плюшевые шляпы
- Верхние шляпы
- Подтяжки
- Кошельки и держатели карт
- Вязаные шарфы
- Штаны цепочки
- Наручки
- Стельки
- Маски для лица
- Повязки
- Наушники
- Ювелирные коробки
- Очки аксессуары
- Солнцезащитные рукава
- Скидка на пакет аксессуаров
- Клавицы
- Немецкие часы
- Золотой браслет
- Жемчужные браслеты
- Гетианские нефриты
- Прекрасные нефритовые браслеты
- Бейсболки
- Шляпы и кепки
- Шарфы и платки
- Спортивные ремни
- Сумки для макияжа
- Другие аксессуары
- Японские / корейские часы
- Нефритовые браслеты
- Функциональные очки
- Другие шляпы
- Ожерелья и подвески
- Браслеты и браслеты
- Часы
- Шарфы
- Волосы
- Другие аксессуары для обуви
- Браслеты
- Цепочки тела
- Глазные маски
- Цепочки очков
- Швейцарские часы
- Подвески
- Гетианские нефриты браслеты
- Настенные часы
- Фитнес -перчатки
- Игрушки
- Пузырьковые машины
- Строительные блоки
- Боевые карты
- Модели аксессуары
- Шариковые куклы
- Другие модели
- Аниме / магниты холодильника аниме / игр
- Значки
- Игрушечное оружие
- Искусство игрушки
- Кукол продуктов
- Бонусные подарки
- Оцениваемые карты
- Карты аксессуары
- Продукты на основе трендов
- IP/аниме -карты
- Торговые карты и другие
- Загадки
- COS реквизит
- Куклы
- Модные фигуры
- Модельные наборы
- Аниме товары
- Акриловые стойки
- Образовательные игрушки
- Куклы
- Фигуры чиби
- Масштабные цифры
- Собранные модели
- Фигуры действий
- IP Merch
- Инструменты моделирования
- Модели и головоломки
- Настольные игры
- Статуи
- Игрушки других детей
- Спортивные карты
- Умные игрушки
- Обувь от poizon
- Закрытые тапочки
- Река -треккинговые туфли
- Детские тапочки
- Челси сапоги
- Середина кальф. Сапоги
- Одеваться в туфли
- Сапоги на открытом воздухе
- Мартин Сапоги
- Шлепки
- Стильные сандалии
- Женская повседневная обувь
- Эспадриль
- Плоды
- Лодочные туфли
- Слайд -тапочки
- Пляжные сандалии
- Зимние сапоги
- Сапоги из котенка
- Мужская случайная обувь
- Обувь на платформе
- Гоммино лоферы
- Детские сандалии
- Сапоги с высоты колена
- Высокие каблуки
- Лоферы
- Мария Джейн туфли
- Сандалии и шлепанцы
- Ботильоны
- Модная обувь
- Одеваться в туфли
- Римские сандалии
- Сапоги детские
- Дождь ботинки
- Детские кожаные туфли
- Сапоги
- Повседневная обувь
- Сандалии с одним ремнем
- Засоры
- Сумки
- Ящики для хранения
- Наплечные сумки
- Сумки для ноутбука
- Туристические сумки
- Рюкзаки
- Фанни упаковывает
- Сумки
- Пакетные аксессуары
- Багажные бирки
- Другие сумки
- Мешки запястья
- Струнки
- Тренажерный зал
- Рюкзаки
- Клатчи и браслеты
- Сцепления
- Портфель
- Сумки для плавания
- Сумки для туристов и туристических
- Студенческие рюкзаки
- Детские сумки
- Сумочки
- Сумки для задниц и сумки для ремней
- Наплечные сумки
- Сумки по перекрестному телу
- Сумочки
- Сумки по перекрестному телу
- Сумки для хранения
- Товары для спорта
- Плавание кепков
- Рыбный крючок
- Плавание
- Браслеты
- Потные полосы
- Защитные шестерни для бокса
- Велосипедные замки
- Бейсбольные перчатки
- Защитные шестерни для катания на катаниях
- Аксессуары для настольного тенниса
- Настольный теннис
- Тэквондо оборудование
- Дайвинг -ласты
- Сувениры бадминтона
- Футбольный фанат сувенир
- Рыбная линия
- Йога оборудование
- Настольный теннисный каучук
- Футбольные голени
- Водонепроницаемые сумки
- Другое плавательное оборудование
- Коленные группы
- Пинг -понг весла
- Прыжки веревки
- Бадминтон Ракетки Сумки
- Роликовые коньки
- Баскетбол
- Вратарь перчатки
- Пояс тяжелой атлетики / тренажеры
- Лодыжка
- Фасция шарики
- Йога носилки
- Мяч для гольфа
- Гантели
- Подшипники скейтборда
- Бильярдные перчатки с тремя пальцами
- Носовые клипы
- Коленные прокладки
- Полосы сопротивления
- Брюшные ролики
- Лопасти с пинг -понгом
- Другие спортивные защитные передачи
- Ракетки бадминтона
- Локоть прокладки
- Оборудование для баскетбола
- Йога блоки
- Водные игрушки
- Фитнес -батончики
- Другое футбольное оборудование
- Бадминтонные сети
- Другие нишевые ракетные виды спорта
- Наружное водное оборудование
- Футбольный
- Рыболовные аксессуары
- Шаттлекоки
- Рыбалка
- Защитные наборы передач
- Доски лежа
- Баскетбол
- Другое оборудование для верховой езды
- Задняя поддержка брекетов
- Спортивные тренажеры
- Лыжные защитные шестерни
- Лента бадминтона
- Волейбол
- Пенопластовые ролики
- Фрисби
- Охранники ног
- Чайники
- Велосипедные насосы
- Сумки на открытом воздухе
- Охранники
- Плавать кольца
- Отжимания рамки
- Скейтборд защитных передач
- Водяные лыжные перчатки / аксессуары
- Лыжные перчатки
- Лыжные ботинки
- Лыжные привязки
- Схватить
- Боксерские перчатки
- Колеса для скейтборда
- Другое оборудование для бадминтона
- Другое баскетбольное оборудование
- Теннисные ракетки
- Сайца
- Продолжительное оборудование
- Йога шарики
- Плавающие доски / плавучие доски
- Теннисные мячи
- Боксерские аксессуары
- Фрисби перчатки

441.00 ₽